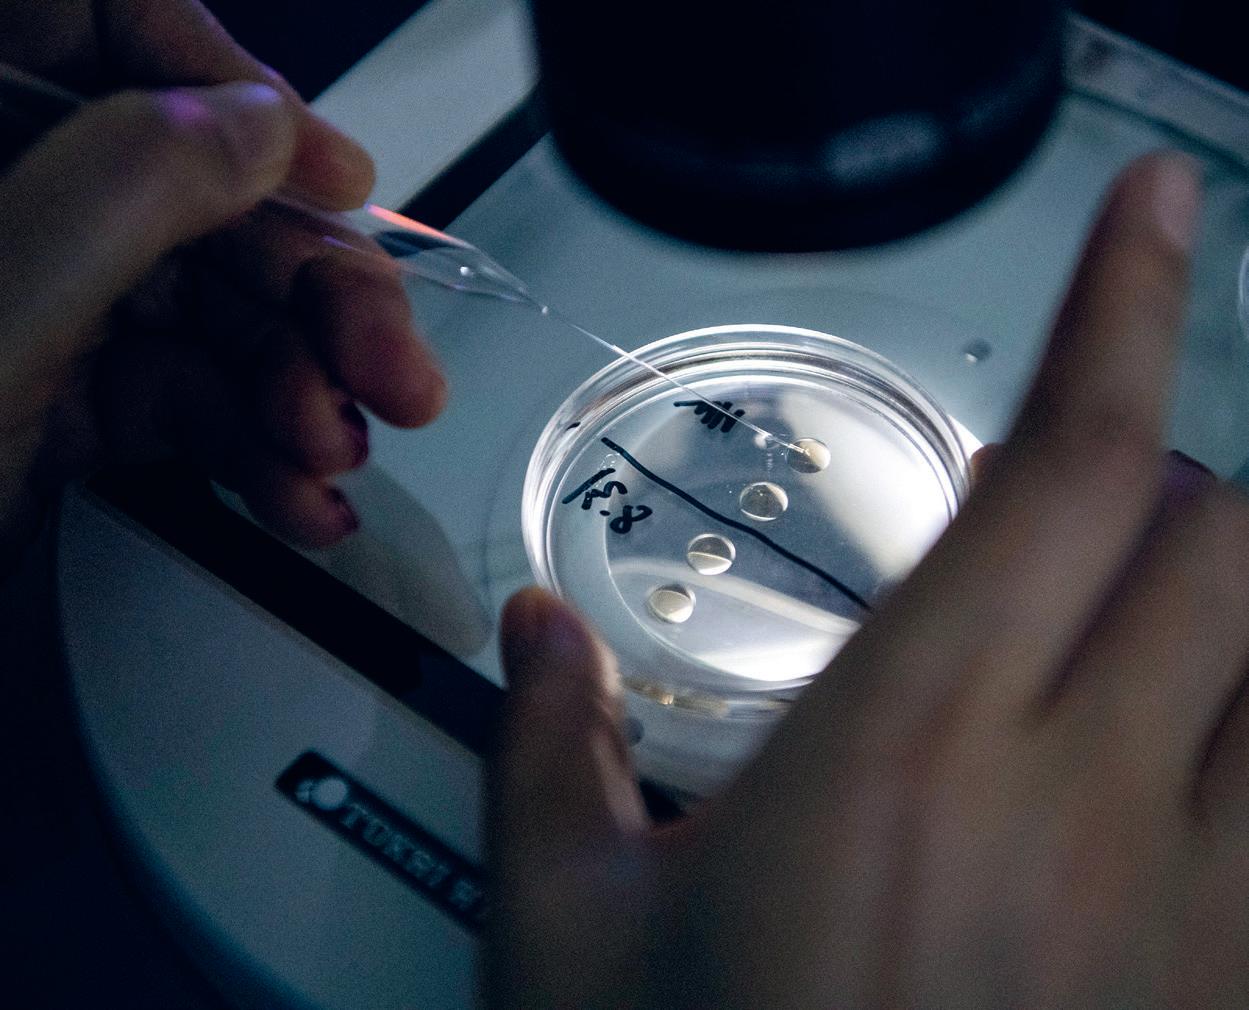

BIOLOGI
FÖR GYMNASIET NIVÅ 2

Jane Goodall (1934–2025) var en brittisk etolog som studerade beteende hos vilda schimpanser.
Hon kom dem nära och gjorde viktiga upptäckter som att de tillverkade verktyg och åt kött. 1986 bytte hon fokus till art- och naturskydd. I nästan
40 år var hon på resande fot för att föreläsa och öka medvetandet om hotade arter och naturmiljöer.
NATIONALENCYKLOPEDINS
biologi
FÖR GYMNASIET NIVÅ 2
NE Nationalencyklopedin AB Ångbåtsbron 1, 211 20 Malmö redaktionen@ne.se www.ne.se
© NE Nationalencyklopedin AB 2026
Författare: Rikard Ask, Magnus Ehinger, Martin Granbom, Mona Jensen, Per Jensen, Fredrik Johansson, Låtta Skogh, Magnus Sylvén
Faktagranskare: Lars Andersson, Fredrik Bengtsson, Nils Cronberg, Johan Jakobsson, Dan Larhammar, Henrik Nilsson, Nina Palmqvist Öberg, Malin Parmar, Allan Rasmusson
Läromedelsutvecklare: Jesper Sörensson
Redaktör: Låtta Skogh
Bildredaktörer: Martina Eriksson och Låtta Skogh
Grafisk form: Jens Klaive
Grafiska redaktörer och layout:
Arvid Gruvö Wärle och Ellen Rönn
Detta verk är skyddat av upphovsrättslagen. Kopiering, utöver lärares och studenters begränsade rätt att kopiera för undervisningsändamål enligt Bonus Copyright Access kopieringsavtal, är förbjuden. För information om avtalet hänvisas till utbildningsanordnarens huvudman, t.ex. kommun, eller Bonus Copyright Access. De flesta skolor och högskolor har avtal med Bonus Copyright Access och har därigenom viss kopieringsrätt. Det är lärarens skyldighet att kontrollera att skolan har ett giltigt kopieringsavtal med Bonus Copyright Access. Den som bryter mot lagen om upphovsrätt kan åtalas av allmän åklagare och dömas till böter och fängelse i upp till två år samt bli skyldig att erlägga ersättning till rättsinnehavaren.
Tryckt hos GPS Group i Bosnien-Hercegovina, 2026
Första upplagan, första tryckningen
ISBN 978-91-89915-38-1
förord
Välkommen till Nationalencyklopedins biologi för gymnasiet nivå 2. Läromedlet är omarbetat och uppdaterat i grunden enligt Gy25.
För att du på bästa sätt ska kunna ta till dig innehållet presenteras och förklaras centrala begrepp i början av varje avsnitt. Varje avsnitt avslutas med sammanfattning, instuderingsfrågor och övningar som hjälper dig att förstå och använda dina kunskaper i praktiken. I diskussionsövningar får du möjlighet att utbyta tankar med dina klasskamrater och utveckla din förmåga att argumentera. I andra övningar får du söka, tolka, värdera och använda information.
I NE:s digitala läromedel kompletteras innehållet i boken med bland annat filmer, extramaterial och ytterligare övningar.
Med den här boken får du inte bara faktakunskaper – du får verktyg för att kunna analysera och resonera kring komplexa frågor. Vår förhoppning är att väcka din nyfikenhet och öka din förståelse för hur din kropp och resten av livet på jorden fungerar.
Redaktionen, NE
1.1
KAPITEL 1:
innehåll
2.1
2.2
2.3
KAPITEL 2:
Fördjupningar
Laborationer
KAPITEL 1:
Cellbiologi

Celler upptäcktes först efter att mikroskopet hade uppfunnits. Efter hand som mikroskopen har blivit mer avancerade har forskare upptäckt fler och fler detaljer. Men cellbiologi handlar till stor del om processer som inte ens kan ses i mikroskop utan studeras med andra metoder.
AVSNITT 1: Frå N b EF ru KTNIN g TILL IN d IVI d
Vid befruktningen skapas vår första diploida cell. Den delar sig, och i början är alla celler identiska. Men efter ett tag börjar skillnader dyka upp. Huvud, armar, ben och inre organ anläggs på rätt plats och får rätt form och funktion.
Hur
går
det till?
ORD OCH BEGREPP
Blastocyst är ett tidigt utvecklingsstadium hos däggdjur som består av en ihålig boll av celler med en inre cellmassa.
Differentiering är en process där olika gener aktiveras och stängs av på ett kontrollerat sätt.
Gastrulation är en process där blastocystens inre cellmassa utvecklas till en blivande kropp.
Groddblad är de tre cellager som bildas under gastrulationen och som bygger upp olika delar av kroppen.
HOX-gener är en grupp gener som bestämmer var olika kroppsdelar ska placeras, till exempel var armar och ben ska växa ut.
Implantation är att blastocysten växer in i slemhinnan på insidan av livmoderns vägg.
Ontogeni är en enskild individs utveckling från befruktad äggcell till könsmogen vuxen.
Ryggsträng är en stavformad struktur i ryggen hos embryon som ger stadga och utsöndrar signalämnen som styr utvecklingen.
Signalmolekyl är ett ämne som sprids i embryot och berättar för cellerna var de befinner sig och vad de ska bli.
Zygot är den diploida cell som bildas när en äggcell befruktas av en spermie.
Livet på jorden uppstod för cirka 4 miljarder år sedan. Därefter har det fortsatt och nya generationer tillkommer ständigt.

När börjar livet?
När börjar livet? Det finns många som skulle säga att det är när en äggcell och en spermie smälter samman till en zygot, eller kanske när hjärtat börjar slå. En del säger att det är först vid födseln som livet börjar, medan andra säger att ”livet börjar vid 30”.
En biolog skulle kanske i stället säga att livet började någon gång för cirka 4 miljarder år sedan. Sedan dess har det bara fortsatt. Både äggcellen och spermien som befruktar den är levande. Livet börjar alltså inte vid befruktningen utan det fortsätter.
En av egenskaperna som utmärker liv är utveckling. När man pratar om livets utveckling kan man syfta på antingen fylogeni eller ontogeni. Fylogeni är utvecklingen av en biologisk grupp. Den utvecklingen har skett till följd av evolution genom naturligt urval. Fylogeni handlar om hur utdöda arter gett upphov till nutida och hur olika nutida arter är besläktade med varandra. Fylogenetiska träd visar hur nu levande organismer har utvecklats och är besläktade med varandra. Ontogeni är en individs utveckling från befruktad äggcell till könsmogen och vuxen. Den utvecklingen sker genom att celler delar sig och specialiseras (differentierar). Detta styrs och regleras noga av gener.
Evo-devo (evolutionary developmental biology) är ett biologiskt forskningsfält där man jämför ontogenin hos olika biologiska grupper för att studera hur evolutionen gått till när befintliga egenskaper förändrats och nya egenskaper uppstått. Man kan till exempel jämföra hur gener styr utvecklingen av frambenen hos olika däggdjur och hur olikheterna leder till att kaniner utvecklar framtassar medan fladdermöss utvecklar vingar.
Befruktning och embryoutveckling
Könscellerna – hos djur spermier och äggceller – bildas genom meios
Då halveras antalet kromosomer så att könscellen blir haploid (ett exemplar av varje kromosomtyp). När en spermie och en äggcell smälter samman bildas återigen en diploid cell (två exemplar av varje kromosomtyp).
Vid ägglossningen, som hos människan inträffar cirka 14 dagar efter den senaste mensens första dag, lossnar en mogen äggcell från äggstocken. Äggledaren är formad som en tratt och med hjälp av piskande cilier på trattens insida leds äggcellen in i äggledaren.
Om äggcellen medan den befinner sig i äggledaren träffar på en spermie kan befruktning ske. Äggcellen släpper in en spermie som har ”rätt” ytegenskaper. Efter att en spermie släppts in förändras äggcellens yttre struktur, vilket hindrar att fler spermier släpps in.

Äggcell och spermier vid provrörsbefruktning (in vitro-fertilisering). Bilden är tagen med ljusmikroskop.
Spermiens väg till äggcellen
Vid den manliga utlösningen sprutas 300–400 miljoner spermier ut. Utlösningen placerar sädesvätskan längst in i slidan, kring livmodertappen.
Spermier sugs upp i livmodern och mot äggledarna av muskelsammandragningar som stimuleras dels av kvinnans orgasm, dels av ämnen i sädesvätskan. Flimmerhåren på insidan av äggledarna skapar vätskeströmmar som hjälper till. Med hjälp av sin svans simmar spermierna den sista korta sträckan till ägget.

En blastocyst. Den inre cellmassan (mörkare grå) innehåller de celler som kommer att ge upphov till själva embryot. Bilden är tagen med ljusmikroskop.
ÄGGKLYVNING
När äggcellen har befruktats och bildat en diploid zygot börjar den dela sig. Hos människan sker den första delningen 1–2 dagar efter befruktningen, samtidigt som zygoten transporteras mot livmodern med hjälp av cilier på insidan av äggledarens vägg. I början sker celldelning utan att cellerna växer. Det bildas först två celler, sedan fyra, därefter åtta och sexton och så vidare. Detta kallas äggklyvning och sker på olika sätt inom olika organismgrupper. Hos människan och andra däggdjur sker äggklyvningen så att dottercellerna blir lika stora. Cellklumpen som bildas kallas morula
Cellerna i morulan fortsätter dela sig, och cellklumpen utvecklas till en ihålig blåsa, en så kallad blastula . Hos däggdjur kallas blastulan för blastocyst . Cellerna i blastocystens vägg kommer att ge upphov till fosterhinnorna och moderkakan. Inne i blåsan finns den inre cellmassan, som kommer att utvecklas till själva embryot. I den inre cellmassan är alla celler fortfarande lika varandra. Dessa celler kan odlas i laboratorium som så kallade embryonala stamceller (ES-celler, se fördjupning om stamceller på sidan 17).
Från ägglossning till implantation.
äggcell
IMPLANTATION
Implantation innebär att blastocysten växer in i slemhinnan på insidan av livmoderns vägg. Hos människan sker detta nio dagar efter befruktningen. Implantationen är en känslig process och lyckas bara för ungefär två tredjedelar av alla befruktade ägg.
Den del av blastocystens vägg som har kontakt med livmoderns slemhinna utvecklas till moderkakan, en struktur som fungerar som en adapter mellan mamman och fostret. Den överför syre och näring från mamman till fostret och transporterar bort koldioxid och slaggprodukter som fostret bildar. I moderkakan finns blodkärl med blod från fostret. Dessa omges av mammans blod som flyter i hålrummen kring kärlen så att ämnesutbyte kan ske utan att blodet blandas.
GASTRULATION
Gastrulation innebär att blastocystens inre cellmassa, där alla celler är lika, utvecklas till en blivande kropp. Den får ett fram och ett bak samt ett upp och ett ner. När gastrulationen är genomförd har det bildats en struktur som kallas gastrula . Den färdiga gastrulan består av tre groddblad, eller cellager, vilka kommer att ge upphov till kroppens alla olika vävnader och organ:
p Ektoderm (’ytterhud’) ger upphov till överhuden, naglarna och håret samt nervsystemet och sinnesorganen.
p Mesoderm (’mellanhud’) ger upphov till bland annat blod och blodkärl, skelett och muskler samt njurar och äggstockar/testiklar.
p Endoderm (’innerhud’) ger upphov till mag–tarmkanalen och dess organ samt lungorna.
Gastrulationen sker på olika sätt inom olika djurgrupper. Hos däggdjur bildar blastulans inre cellmassa en avlång groddskiva som till att börja med består av två cellager. Vid gastrulationen vandrar celler på groddskivans yta mot en mittlinje, där de sjunker in och bildar det tredje lagret. Hos människan har de tre groddbladen bildats 18 dagar efter befruktningen.
RYGGSTRÄNG
Hos alla ryggsträngsdjur (manteldjur, lansettfiskar och ryggradsdjur) bildas i samband med gastrulationen en ryggsträng. Ryggsträngen är viktig under embryoutvecklingen av två anledningar: dels ger den kroppen form och stadga, dels utsöndrar den det viktiga signal
”It is not birth, marriage or death, but gastrulation which is truly the most important time in your life.”
UTVECKLINGSBIOLOGEN
LEWIS WOLPERT (1929–2021)
Fostrets ålder
Biologer anger ett fosters ålder i dagar eller veckor efter befruktningen. Barnmorskor och förlossningsläkare anger att graviditetens längd är tiden i veckor efter den senaste mensens första dag (eftersom det ofta är svårt att veta exakt när befruktningen har skett). Eftersom ägglossning och befruktning sker cirka två veckor efter senaste mensens första dag är fostrets ålder cirka två veckor mindre än graviditetens längd. För att undvika missförstånd är det bra att ange om man pratar om fostervecka eller graviditetsvecka.
ämnet sonic hedgehog. Hos lansettfiskar finns ryggsträngen kvar hela livet och ger den vuxna individen stadga. Hos ryggradsdjur ersätts ryggsträngen under embryots utveckling av en ryggrad.
NERVRÖR
Ryggsträngens Sonic Hedgehog-signaler påverkar den del av ektodermet som befinner sig rakt ovanför så att det förtjockas och sedan veckas inåt. Veckets kanter förtjockas ytterligare och möts så att det bildas ett ihåligt rör, det så kallade nervröret. Nervröret utvecklas efter hand till ryggmärg, hjärna och sinnesorgan.
Hos människan börjar vecket bildas 18 dagar efter befruktningen. Nervröret sluts tio dagar senare, fyra veckor efter befruktningen.
SOMITER
På vardera sidan om ryggsträngen bildas i mesodermet par av segment som kallas för somiter. Hos människan bildas det första paret somiter 20 dagar (knappt tre veckor) efter befruktningen. Hos vuxna individer syns somiterna tydligast hos fiskar (segmenten som bygger upp en fiskfilé). Hos människan ger somiterna upphov till de enskilda halsoch ryggkotorna, revbenen och magmusklernas rutor.

Ett människofoster fem veckor efter befruktning är cirka 2 millimeter långt (ungefär lika stort som ett sesamfrö). Främre delen av nervröret har börjat utvecklas till hjärnan (blåsorna överst på bilden).
Differentiering
I början av en individs utveckling är alla celler likadana. När det blivande fostret bara består av åtta celler kan fortfarande var och en av dessa bilda en hel individ samt moderkaka och fosterhinnor. Men sedan börjar skillnader uppstå. Cellerna blir olika, och vilka sorters celltyper de kan ge upphov till begränsas. Man säger att cellerna börjar differentiera.
Att något differentierar betyder att det skapas skillnader inom något som först var enhetligt. Differentieringen som leder till att kroppens olika celltyper utvecklas sker genom att olika uppsättningar av gener blir aktiva.
SIGNALMOLEKYLER
I det tidiga embryot bildar vissa celler speciella signalmolekyler som diffunderar ut i vävnaden och berättar för cellerna runt omkring var i embryot de befinner sig. Nära platsen där en signalmolekyl bildas är koncentrationen hög, längre bort är den lägre. Beroende på hur hög koncentrationen av olika signalmolekyler är på platsen där en cell befinner sig kommer cellen att aktivera olika transkriptionsfaktorer. Detta leder till att komplicerade strukturer som hjärna och ryggrad kan utvecklas på rätt plats och sätt.
Vitamin A-syra är en signalmolekyl som börjar bildas redan under gastrulationen. Ämnet påverkar cellers förflyttning och differentiering i flera delar av embryot och är bland annat helt avgörande för att bestämma vad som ska bli huvud och vad som ska bli svans. För att ett embryo ska utvecklas normalt måste vitamin Asyra bildas och frisättas på rätt platser, vid rätt tillfällen och i rätt nivåer. Både för mycket och för lite vitamin Asyra kan orsaka missbildningar i bland annat hjärnan och hjärtat.
Vitamin A-syra samspelar med andra ämnen, bland annat tillväxtfaktorer och transkriptionsfaktorer. Vitamin Asyra och transkriptionsfaktorn TBX1 dämpar till exempel varandra. Ökning av den ena minskar nivån av den andra och tvärtom, minskning av den ena ökar nivån av den andra. Personer som saknar den del av kromosom 22 där genen för TBX1 sitter får en förhöjd vitamin A-syra-signalering, vilket leder till missbildningar i bland annat thymus, bisköldkörtlarna, mjuka gommen, ibland i ansiktet och hjärtat (sammantaget kallat DiGeorges syndrom).

En morula cirka fyra dagar efter befruktning. Det är vid detta stadium differentieringen börjar. Bilden är tagen med svepelektronmikroskop (SEM) och digitalt färglagd.
Namnet sonic hedgehog
Proteinet sonic hedgehog har fått sitt namn efter datorspelsfiguren Sonic the Hedgehog som är en blå igelkott. Namnet valdes eftersom fluglarver som har en mutation i genen som kodar för proteinet blir taggiga.
Signalmolekylen sonic hedgehog (SHH) är ett protein som bildas och frisätts av ryggsträngen och som styr en stor del av embryots tidiga utveckling. SHH stimulerar bland annat bildningen av nervröret och utvecklingen av nervsystemet, utvecklingen av somiter, utvecklingen av njurar och lungor samt anläggningen av armar och ben.
SHH diffunderar från ryggsträngen ut i vävnaden. Det bildas en koncentrationsgradient med högst koncentration närmast ryggsträngen och lägre koncentration längre bort. Olika hög koncentration av SHH påverkar celler på olika sätt genom att olika gener aktiveras respektive stängs av. Ett exempel är att delning av vissa celler i nervsystemet dämpas av hög SHH-koncentration men stimuleras av låg SHH-koncentration.
TILLVÄXTFAKTORER
Tillväxtfaktorer är proteiner som binder till specifika receptorer på cellytan, vilket via molekylära signaler stimulerar celler till att dela sig, växa eller differentieras. Det finns många olika tillväxtfaktorer. Vissa är generella medan andra är mycket specifika. Nervtillväxtfaktor är ett exempel på en specifik tillväxtfaktor och påverkar bara bildande och tillväxt av nervceller.
TRANSKRIPTIONSFAKTORER

Ett komplex av två transkriptionsfaktorer (Hoxb1 och Pbx1, lila och rosa) som binder till en DNA-molekyl (grön och orange).
En transkriptionsfaktor är ett protein som kontrollerar transkriptionen av en viss gen, det vill säga hur mycket av genens protein som bildas. Transkriptionsfaktorn gör detta genom att binda till ett avsnitt av DNAmolekylen i närheten av genen. Under ontogenin är många transkriptionsfaktorer inblandade. Som svar på olika signaler aktiverar transkriptionsfaktorerna specifika gener, vilket leder till att cellernas egenskaper förändras. Vilka transkriptionsfaktorer som bildas var i embryot regleras noga, bland annat med hjälp av signalmolekylerna Sonic Hedgehog (SHH) och vitamin Asyra som fungerar som positionssignaler som berättar för celler var i embryot de befinner sig. Beroende på koncentrationen av SHH och vitamin Asyra aktiveras olika transkriptionsfaktorer, vilket är mekanismen bakom att organen hamnar på rätt plats.
HOX-proteiner är en grupp transkriptionsfaktorer som styr viktiga processer under utvecklingen hos både flugor och människor. Genom att öka respektive minska transkriptionen av olika gener påverkar hox-proteinerna hur celler delar sig, klibbar fast vid varandra, flyttar
på sig och dör via apoptos (programmerad celldöd). På så sätt regleras bland annat bildningen och utvecklingen av somiter, och i förlängningen vilka kroppsdelar som bildas var. Generna för hox-proteinerna kallas hox-gener. Alla Hox-gener innehåller en så kallad homeobox, en DNAsekvens som är omkring 180 baspar lång. Den del av proteinet som motsvaras av homeoboxen kallas homeodomänen. Homeodomänen är 60 aminosyror lång och utgör den del av hox-proteinet som kan binda till andra gener på DNAmolekylen och på så sätt påverka transkriptionen av dessa.
SAMMANFATTNING
* Livet började för 4 miljarder år sedan.
* En av egenskaperna som utmärker liv är utveckling.
* Vid befruktning smälter ägg och spermie samman till en zygot som genom celldelning utvecklas till en ihålig blåsa (blastula).
* Implantation innebär att ett embryo växer fast i livmoderns slemhinna för att kunna ta emot näring.
* Under gastrulation sorteras ett embryos celler i tre lager som senare bygger upp kroppens alla organ.
* Ryggsträngen ger embryot stadga och skickar signaler som styr hur nervsystemet bildas.
* Differentiering är en process där celler specialiseras till olika typer, som hud eller muskler, genom att gener slås på eller av.
INSTUDERINGSFRÅGOR
1. När börjar livet ur ett biologiskt perspektiv?
2. Vad menas med fylogeni respektive ontogeni?
3. Ge exempel på en forskningsfråga inom evo-devo.
4. Vad händer med kromosomantalet när en äggcell och en spermie smälter samman? Vad kallas den cell som bildas?
5. Vad är äggklyvning? Vad kallas cellklumpen som bildas hos däggdjur i detta stadium?
6. Vad menas med implantation? När sker den hos människan?
7. Ge exempel på vad vart och ett av de tre groddbladen ger upphov till under gastrulationen.
8. Vad är en totipotent stamcell? Fram till vilket stadium är cellerna totipotenta hos människa?
9. Hur fungerar transkriptionsfaktorer?
ÖVNINGAR
Evo-devo
Vad studerar evo-devoforskare för att avgöra hur förändringar i genreglering kan leda till nya strukturer under utvecklingen, till exempel hur hox-gener styr var olika kroppsdelar bildas?
Aborträtt
Aborträtten är ingen självklarhet i alla länder. Ett av argumenten mot abort är att abort är mord.
a) Värdera argumentet och fundera över din egen ståndpunkt.
b) Ta reda på när ett embryo övergår till att bli ett foster. Hur är tidpunkten för aborträtt satt i olika länder?
c) Går gränsen för mänskligt värde vid ett embryo eller ett foster? Har en befruktad cell (zygot) mänskligt värde? Diskutera i par.
IPS-celler
Om embryonala stamceller ersätts av iPS-celler i forskning och kloning, vilka etiska problem löses – och vilka kvarstår?
Odla organ
Vilka är utmaningarna med att odla organ från pluripotenta stamceller utanför kroppen?
HeLa-celler
På laboratorier världen över finns så kallade HeLa-celler som alla kommer från den cancersjuka kvinnan Henrietta Lacks. Sök information om Henrietta Lacks och diskutera om man borde ha ”copyright” på sina celler?
FÖRDJUPNING
Stamceller
En stamcell är en omogen cell som delar sig och ger upphov till mer differentierade celler och till fler stamceller. De första cellerna som bildas när den befruktade äggcellen börjar dela sig är totipotenta stamceller. Det betyder att de kan ge upphov till precis alla typer av celler i kroppen och dessutom till moderkaka och fosterhinnor. Efter hand som embryot växer bildas celler som är mer och mer begränsade beträffande vilka celltyper de kan ge upphov till.
Olika sorters stamceller Stamceller kan delas in efter hur många celltyper de kan ge upphov till, det vill säga deras grad av potens.
Totipotenta stamceller kan ge upphov till en helt ny individ, inklusive moderkaka och fosterhinnor. Hos människan är cellerna totipotenta fram till 8-cellstadiet.
Pluripotenta stamceller kan ge upphov till alla celltyper i hela kroppen, men inte till moderkaka och fosterhinnor. I blastocystens inre cellmassa är cellerna pluripotenta.
Multipotenta stamceller kan ge upphov till flera olika celltyper. Ett exempel är de hematopoetiska stamceller som under hela livet finns i benmärgen och ger upphov till alla typer av blodkroppar.
Unipotenta stamceller kan bara ge upphov till en typ av mogen cell. Exempel är satellitceller i muskler (som bara kan bilda nya muskelceller)
och spermatoginier i testiklarna (som bara kan bilda spermier).
Utvecklingen från multipotent stamcell till mogen specialiserad cell går oftast via ett (eller flera) mellansteg.
Celler i detta stadium kallas progenitorceller eller prekursorceller. De är något mer differentierade och kommer bara att dela sig ett begränsat antal gånger för att ge upphov till ett fåtal celltyper.
Exempel är neuroblaster som bara bildar nervceller och myoblaster som bara bildar muskelceller.
Stamceller i labbet
Stamceller används i många typer av biomedicinsk forskning. Cellerna hämtas då ofta från ett värddjur och odlas sedan i laboratorium under kortare eller längre tid. De delas ofta in efter vilken ålder värden hade när cellerna hämtades.
Embryonala stamceller (ES-celler) är celler från den inre cellmassan i blastocysten. Humana ES-celler kommer från befruktade äggceller som ”blivit
över” vid IVF-behandlingar. De är pluripotenta och kan ge upphov till alla olika celltyper i organismen.
Fosterstamceller kommer från embryon eller foster. Humana fosterstamceller kommer från aborterade foster eller från navelsträngen. De är multipotenta och kan ge upphov till flera celltyper.
Adulta stamceller är stamceller som finns utspridda i kroppens olika organ och har som uppgift att ersätta celler som dör eller skadas. De flesta adulta stamceller är multipotenta men de kan också vara unipotenta.
Inducerat pluripotenta stamceller (iPS-celler) är pluripotenta stamceller som framställts genom att man tagit differentierade bindvävsceller från en vuxen individ och påverkat dem till att börja bilda fyra speciella transkriptionsfaktorer. Detta leder till att cellerna programmeras om och börjar bete sig som embryonala stamceller. Läs mer om iPS-celler i avsnittet Kloning i kapitlet Bioteknik och genteknik

Embryonala stamceller avbildade med svepelektronmikroskop (SEM) och digitalt färglagda.
AVSNITT 2: VäVNA d E r och SPE c IALISE r A d E c ELLE r
Djur är uppbyggda av fyra huvudtyper av vävnader: epitelvävnad, stödjevävnad, nervvävnad och muskelvävnad. För att vävnaderna ska kunna utföra sina uppgifter måste cellerna de består av ha olika egenskaper. Körtelceller måste kunna tillverka sina produkter, nervceller måste kunna skicka nervsignaler.
ORD OCH BEGREPP
Axon är det utskott på en nervcell som leder signaler ut från cellkroppen till andra celler.
Dendriter är de utskott på en nervcell som tar emot signaler från andra celler och leder dem in till cellkroppen.
Epitelvävnad är vävnad som täcker kroppens ytor (huden) och inre hålrum och avgränsar kroppen mot omgivningen.
Extracellulärt matrix är en substans av proteiner och andra ämnen som
omger celler i bindväven och ger dem dess styrka eller elasticitet.
Fibroblast är den vanligaste celltypen i bindväv.
Gliaceller är olika typer av stödjeceller i nervsystemet.
Körtelceller är specialiserade celler i epitelvävnad som tillverkar och utsöndrar ämnen som svett, saliv eller hormoner.
Neuron är den celltyp i nervsystemet som ansvarar för att skapa och skicka vidare elektriska signaler.
Stödjevävnad är ett samlingsnamn på olika slags vävnad som ger kroppen struktur och håller organen på plats.
Synaps är kontaktpunkten där en nervsignal överförs kemiskt från en cell till en annan med hjälp av signalsubstanser.

Epitelvävnad
Under de flercelliga djurens evolution var epitelvävnad den första vävnaden som utvecklades. Epitelvävnad täcker kroppsytan och skiljer organismen från omgivningen. Tack vare epitelvävnaden kan djur ha en inre miljö med andra kemiska och fysikaliska förutsättningar än de som finns i miljön runt omkring. Hos de allra enklaste flercelliga djuren (svampdjur) täcks kroppsytan av ett lager av celler som är lite enklare uppbyggt och inte sluter lika tätt mot omgivningen, men hos alla andra djur finns äkta epitelvävnad som omsluter hela organismen, både utsidan av kroppen (huden) och de inre håligheterna (mag–tarmkanalen och luftvägarna). Eftersom hålrummen i mag–tarmkanalen och lungorna har direkt förbindelse med yttervärlden räknas även de till kroppens utsida.
I olika typer av epitelvävnad finns olika typer av specialiserade epitelceller, däribland hudceller som bildar hornämne (keratinocyter), tarmceller som tar upp näring (enterocyter), körtelceller som bildar bland annat svett, slem och hormoner samt luftvägsceller som har små hår (cilier) som transporterar slem upp ur luftvägarna.
Epitelvävnadens celler är tätt sammankopplade med varandra med så kallade tight junctions, vilket hindrar vätska och ämnen från att ta sig in eller ut mellan cellerna. Under epitelcellerna finns ett så kallat basalmembran, ett tunt lager av proteiner (kollagen och laminin) som cellerna bildar och som gör epitelvävnaden stabil.
Svampdjur täcks av ett cellskikt som är enklare uppbyggt. Alla andra flercelliga djur har äkta epitel.
Det yttersta lagret av huden (överhuden) består av epitelvävnad.

Att salta och torka fisk är ett traditionellt sätt att konservera den. Den höga salthalten drar ut vatten ur fiskens celler genom osmos. Detta hindrar tillväxt av bakterier som normalt får mat att ruttna.
TRANSPORT ÖVER MEMBRAN
Eftersom epitelcellerna är tätt sammankopplade måste ämnen passera genom själva cellerna för att ta sig in i eller ut ur kroppen. Cellmembranet begränsar vad som kan passera.
Vissa ämnen kan passera genom membranet utan att cellen behöver använda energi. Detta kallas passiv transport och innebär att molekyler rör sig genom diffusion från den sida av membranet där koncentrationen är högst till den andra sidan, där koncentrationen är lägre. Små molekyler som syre och koldioxid kan smita rakt igenom membranet. Kanalproteiner i membranet släpper igenom utvalda molekyler. Akvaporiner är kanalproteiner som släpper igenom vatten. Vattenmolekyler rör sig mot den sida av membranet som har högst koncentration av lösta ämnen (exempelvis salt) för att jämna ut skillnaden. Processen kallas osmos. Om en cell befinner sig i en miljö med lägre salthalt än den har inuti sig kommer vatten att strömma in i cellen genom osmos så att den sväller.
semipermeabelt membran
Om koncentrationen av ett löst ämne är olika på två sidor om ett semipermeabelt membran kommer vatten att flyta in i området med hög koncentration för att utjämna skillnaden så mycket som möjligt.
vatten rör sig genom membranet
låg koncentration av löst ämne hög koncentration av löst ämne
För att kunna kontrollera den inre miljön måste cellerna ibland flytta molekyler från den sida av membranet som har lägre koncentration av ämnet till den sida där koncentrationen är högre. Detta kräver energi (ATP) och kallas aktiv transport . Transportproteiner i membranet pumpar molekyler in i eller ut ur cellen. Sådana pumpar används när tarmen tar upp näring och när njurarna reglerar kroppens saltbalans samt när nervceller skapar nervsignaler.
KÖRTELCELLER
Körtelceller bildar ämnen som utsöndras till blodet, till kroppens yta eller till inre hålrum. Endokrina körtlar utsöndrar sina ämnen, hormoner, direkt till blodet (de saknar utförsgångar). Exokrina körtlar utsöndrar ämnen via utförsgångar till utsidan eller insidan av kroppen. Ämnen som utsöndras på utsidan av kroppen är bland annat svett, mjölk och talg (fett som smörjer huden). Ämnen som utsöndras i kroppens hålrum (till exempel i mag–tarmkanalen) är bland annat saliv, slem, bukspott och galla. Många körtelceller producerar stora mängder proteiner (själva ämnet som de utsöndrar eller enzymer som behövs för att bilda det) och har därför ett välutvecklat endoplasmanät med många ribosomer och en stor golgiapparat.
Bindväv och andra
stödjevävnader
Stödjevävnader fungerar som ett slags fogmassa som håller ihop den flercelliga organismen samt ger kroppen struktur, stöd och skydd. Svampdjur och nässeldjur innehåller en föregångare till stödjevävnad, men äkta stödjevävnader utvecklas från gastrulans mellersta groddblad (mesoderm), vilket finns hos djur med ett fram och bak, upp och ner samt en spegelvänd höger och vänstersida (bilateria). Hos människan och andra ryggradsdjur bildar mesodermet flera typer av stödjevävnader: bindväv, broskvävnad, benvävnad, fettvävnad och flytande vävnader (blod och lymfa).
Bindväv består av dels olika typer av specialiserade bindvävsceller (fibroblaster), dels ett så kallat extracellulärt matrix som omger cellerna. Extracellulärt matrix består av stora mängder strukturproteiner, bland annat kollagen och elastin, samt andra ämnen som proteoglykaner och hyaluronsyra. Kollagen gör vävnaden stark och tålig, elastin gör den elastisk. Bindväv med mycket kollagen finns i bland annat senor och muskelfästen, i läderhuden och kring inre organ.
FIBROBLASTER
Fibroblaster är den vanligaste celltypen i egentlig bindväv. De bildar och utsöndrar de ämnen som extracellulärt matrix består av. Liksom körtelceller har fibroblaster därför ett välutvecklat endoplasmanät med många ribosomer och en framträdande golgiapparat. Om bindväven skadas kan fibroblaster börja dela sig och på så sätt delta i läkningen.

Fibroblaster som har odlats i cellodling och färgats med fluorescerande ämnen. Cellkärnorna är blå och cellskelettet (aktin och tubulin) är gult och rött.
Nervvävnad
Nervvävnad gör att djur kan registrera förändringar i den omgivande miljön och reagera genom att aktivera sina muskler och/eller körtlar (all interaktion mellan djur och deras omgivning sker med hjälp av muskler och körtlar). Nervvävnad utvecklades redan hos nässeldjur, till exempel maneter, som har ett nervnät som gör att de kan reagera på beröring och samordna sina enkla rörelser. Hjärnan utvecklades stegvis, från nervknutor ( ganglier) i anslutning till sinnesorgan till ett mer och mer avancerat organ.
Hos människan och andra ryggradsdjur består nervvävnaden av nervceller (som skickar elektriska nervsignaler) och gliaceller (stödjeceller som ser till att miljön kring nervcellerna är bra).
NERVCELLER
Nervceller (neuron) skapar och skickar vidare signaler i nervsystemet. Det finns många olika typer av nervceller. En nervcell har precis som andra celler en cellkropp med cellkärna och andra organeller. Det är nervcellernas cellkroppar som ger upphov till grå hjärnvävnad . Från cellkroppen utgår två typer av utskott: flera dendriter och ett axon.
dendrit cellkropp axonkägla axon nervändslut
En nervcell har flera dendriter men bara ett axon.
Dendriter tar emot signaler från andra nervceller och leder dem till cellkroppen. På dendriten finns kontaktpunkter där nervcellen tar emot signaler från andra nervceller. Från kontaktpunkterna skickas signalerna in till cellkroppen. Beroende på vilken sorts signaler som kommer, och hur starka de är, reagerar nervcellen på olika sätt.
Ett axon leder signaler från cellkroppen till andra celler (nervceller, muskelceller eller körtelceller). Axonet är oftast förgrenat och kontaktar många mottagarceller. Kroppens längsta axoner går från ryggmärgen till foten och är cirka 1 meter långa, medan de kortaste är mindre än 1 millimeter långa.
En synaps är den plats där en signal skickas från en nervcells axon till nästa cells dendrit eller cellkropp. Synapsen består av avsändarens nervändslut (i slutet av axonet), mottagarens kontaktyta och det lilla mellanrummet däremellan (synapsklyftan). När en elektrisk nervimpuls når nervändslutet frisätts signalsubstans (neurotransmittor) ut i synapsklyftan. På mottagarcellen finns receptorer som binder till signalsubstansen och utlöser en reaktion.
Det finns många olika signalsubstanser, en del är stimulerande, andra är dämpande; varje avsändarcell bildar och frisätter bara en sorts signalsubstans. Varje mottagarcell har kontakt med många avsändare. Om flera avsändare skickar stimulerande signaler samtidigt så kommer dessa att läggas ihop till en starkare signal. Om vissa avsändare skickar stimulerande signaler och andra samtidigt skickar dämpande signaler så kan dessa släcka ut varandra. Läs mer om nervsignaler i kapitel Reglering av kroppen , avsnittet Nervsystemet
GLIACELLER
Gliaceller stödjer och skyddar nervcellerna och ser till att miljön kring dem är bra. Det finns många olika slags gliaceller.
Vissa gliaceller sitter virade kring axoner (som en rulltårta) och bildar ett isolerande hölje som kallas myelin. Myelin består av gliacellernas fettrika cellmembran och gör att nervimpulser färdas snabbare (men vissa korta axoner har inget myelin kring sig). Gliaceller som bildar myelin i centrala nervsystemet, det vill säga hjärnan eller ryggmärgen, kallas oligodendrocyter. De som bildar myelin kring axoner ute i kroppen kallas schwannceller.
Astrocyter reglerar den kemiska miljön i hjärnan. De tätar blodkärlen och bidrar till den så kallade blod–hjärnbarriären som hindrar ämnen i blodet från att fritt diffundera in i hjärnan. Astrocyter deltar

En astrocyt i hjärnans grå substans. Hjärnvävnaden har behandlats med en metod som slumpmässigt färgar in ett fåtal celler. Eftersom de kringliggande cellerna är ofärgade blir den färgade cellens form mycket tydlig.
Vänster: glatt muskulatur. Mitten: hjärtmuskulatur. Höger: skelettmuskulatur.
även i hjärnans ämnesomsättning samt sköljer under nattsömnen rent hjärnan från restprodukter som bildats under dagen.
Mikroglia fungerar som ett slags immunceller som städar upp i hjärnan genom att äta upp skadade celler och proteiner samt svaga synapser, vilka sedan bryts ner av cellens lysosomer. Detta sker dels under nattsömnen, dels efter en hjärnskada.
Muskelvävnad
Muskelvävnad liksom stödjevävnad utvecklas från gastrulans mellersta groddblad (mesoderm), vilket finns hos bilaterala djur. (Maneter har celler som kan kontrahera, men det är specialiserade epitelceller.) Muskelvävnad gör att djur kan röra på sina kroppsdelar, men den är också avgörande för funktionen hos många inre organ. Hos ryggradsdjur finns tre typer av muskelvävnad: skelettmuskulatur, hjärtmuskulatur och glatt muskulatur. Skelettmuskulatur bygger upp musklerna som vi använder för att röra på oss samt vissa andra muskler som vi kan styra med viljan, exempelvis musklerna i ansiktet och talapparaten. Skelettmuskulaturen är viljestyrd, kontraherar snabbt och består av flerkärniga, långsträckta, tvärstrimmiga muskelceller (muskelfibrer). Cellerna är fullpackade med proteintrådar (aktin och myosin) som sköter kontraktionen samt mitokondrier som utför cellandningen och producerar det energirika ämnet ATP som krävs för rörelsen.



Hjärtmuskulaturen bygger upp hjärtat. Den är inte viljestyrd, kontraherar rytmiskt och består av förgrenade, tvärstrimmiga hjärtmuskelceller (kardiomyocyter).
Glatt muskulatur finns i luftvägarnas, blodkärlens, mag–tarmkanalens och urinblåsans väggar. Den är inte viljestyrd, kontraherar långsamt och består av spolformiga, icke tvärstrimmiga glattmuskelceller.
SAMMANFATTNING
* Kroppen är uppbyggd av fyra huvudkategorier av vävnader: epitelvävnad, stödjevävnad, nervvävnad och muskelvävnad.
* Epitelvävnad består av tätt sammankopplade celler som täcker kroppens ytor och inre hålrum.
* Stödjevävnad, som ben, brosk, fett och blod, ger kroppen struktur och skydd.
* Nervvävnaden gör att kroppen kan registrera förändringar och reagera genom att skicka elektriska signaler via nervceller.
* Gliaceller skyddar nervcellerna, städar i hjärnan och isolerar nervtrådarna så att signaler går snabbare.
* Muskelvävnad delas in i skelettmuskulatur, hjärtmuskulatur och glatt muskulatur och möjliggör rörelse.
INSTUDERINGSFRÅGOR
1. Varför var epitelvävnad viktig under de flercelliga djurens tidiga evolution?
2. Vad är tight junctions? Vilken funktion har de i epitelvävnad?
3. Vad är basalmembranet? Vilka ämnen består det av?
4. Ge tre exempel på specialiserade epitelceller och vilka uppgifter de har.
5. Vad skiljer endokrina från exokrina körtlar?
6. Vad är extracellulärt matrix? Vilken funktion har kollagen respektive elastin i bindväv?
7. Vad är fibroblaster och vilken roll har de vid vävnadsskador?
8. Vilka två huvudtyper av celler ingår i nervvävnad hos ryggradsdjur?
9. Vad är en synaps? Vad händer där när en nervimpuls når nervterminalen?
10. Nämn de tre typerna av muskelvävnad hos ryggradsdjur och ange en egenskap för varje.
ÖVNINGAR
Vävnadstyper
Organ är uppbyggda av olika typer av vävnad. Vilka olika vävnadstyper finns i:
a) magsäcken?
b) lungorna?
c) hjärtat?
Samverkan mellan vävnadstyper
För vår funktion krävs att olika vävnadstyper fungerar tillsammans. Förklara hur exempelvis nervvävnad och muskelvävnad är beroende av varandra för att vi ska kunna röra oss.
Syntetisk vävnad
Inom medicin försöker man hitta syntetiska alternativ till mänsklig vävnad, exempelvis vätska som fungerar som blod eller tyg som kan fungera som hud vid behandling av brännskador.
a) Vilka egenskaper behöver dessa syntetiska alternativ ha för att kunna fungera effektivt?
b) Varför vill man hitta syntetiska alternativ?
c) Finns det andra vävnader än de ovan nämnda som skulle vara intressanta att hitta alternativ till?
LA
bor ATI o N
Osmos i potatis och sötpotatis
SYFTE
Att undersöka hur vatten rör sig genom osmos in i eller ut ur växtvävnaden genom att placera stavar av potatis och sötpotatis i lösningar av olika salthalt.
MATERIEL
Potatis.
Sötpotatis. Provrör.
Korkborr.
Pincett.
Våg.
Saltlösningar (0 %, 0,5 %, 1,5 %, 2,5 %, 3,5 %, 4,5 % viktprocent NaCl i vatten).
Pappersservetter eller hushållspapper.
Underlägg vid vägning (till exempel bullformar eller aluminiumfolie).
UTFÖRANDE
1. Fyll upp cirka 5 cm av var och en av de sex saltlösningarna i vardera två provrör. Märk provrören tydligt.
2. Använd en korkborr för att stansa ut sex cylinderformade stavar ur potatisarna och sex stavar ur sötpotatisarna. När du ska preparera dina stavar är det viktigt att du inte rör vid dem med händerna utan använder en pincett. Se till att alla tolv stavarna blir lika stora. Skär av dem så att de blir 30 mm långa.
3. Varje stav ska vägas innan den placeras i respektive saltlösning. Använd ett underlägg – lägg inte stavarna direkt på vågen. Kom ihåg att nollställa vågen så att du bara får stavens vikt. Arbeta snabbt för att förhindra att proverna utsätts för torka i onödan.
4. Häll av vätskan efter 30 minuter. Torka snabbt och försiktigt av stavarna med en pappershandduk och väg dem på samma våg och på samma sätt som tidigare. Anteckna resultaten i en tabell.
5. Notera för var och en av stavarna hur ytans textur känns. Släng sedan stavarna i papperskorgen och diska provrören.
Analys av resultaten
1. Räkna ut den procentuella viktförändringen som vikten efter delat med vikten före för var och en de tolv provrören. För in värdena i tabellen.
2. Beräkna klassens medelvärde av den procentuella viktförändringen i respektive salthalt för potatis och för in i tabellen. Gör motsvarande för sötpotatis.
3. Skapa ett punktdiagram där punkterna för potatis respektive sötpotatis är med. Du kan välja att förbinda punkterna med linjer för att resultatet ska bli tydligare.
REDOVISNING
Redovisa laborationen genom att ta med tabell och diagram. Hur stor är salthalten för potatis respektive sötpotatis? Besvara frågorna nedan.
1. Varför skapa stavar av potatisarna? Varför räcker det inte att väga bitarna?
2. Varför är just den procentuella viktförändringen viktig?
3. Vad visar en kvot på 1,00?
4. Vad visar en kvot på mer än 1,00? Mindre än 1,00?
5. Vad säger resultaten om saltkoncentrationen i potatisens respektive sötpotatisens cytoplasma vid början av försöket?
6. Vilka problem finns med metoden som används? Ge förslag på hur metoden kan förbättras.
AVSNITT 3: cELLAN d NIN g
Cellandningen
är
en
av
cellens
viktigaste
processer.
Den frigör energin i kolhydrater, fetter och proteiner som vi ätit. Energin används sedan för att tillverka molekyler, transportera ämnen över membran, skicka nervsignaler och dra samman muskelceller.
ORD OCH BEGREPP
ATP är en förkortning av adenosintrifosfat, cellens energivaluta.
Cellandning är när celler frigör energi ur energirika molekyler genom att förbränna dem med syre.
Citronsyracykeln är cellandningens andra steg, där vätejoner och energirika elektroner frigörs.
Elektrontransportkedjan är cellandningens sista steg, där syre
konsumeras och en stor mängd ATP bildas.
Glukos är en enkel sockerart som cirkulerar i blodet och fungerar som cellernas bränsle.
Glykolys är cellandningens första steg, där glukos klyvs till pyruvat och lite ATP bildas.
Katabolism är när cellen bryter ner stora molekyler för att frigöra energi.
Mitokondrie är den organell där cellandningen sker.
Pyruvat är en molekyl som bildas i glykolysen.
Kroppens energiutvinning
De kemiska reaktioner som sker när kemisk energi utvinns ur mat som vi har ätit kallas katabolism. I mag–tarmkanalen bryts kolhydrater ner till glukos, fetter till glycerol och fettsyror och proteiner till enskilda aminosyror. Dessa ämnen transporteras sedan med blodet ut i kroppen och tar sig in i dess celler med hjälp av olika transportmekanismer.
ENERGIVALUTAN ATP
I cellerna utvinns kemisk energi ur glukos, fettsyror och aminosyror och omvandlas till kemisk energi i energivalutan ATP (adenosintrifosfat). ATP är en molekyl som består av kvävebasen adenin (som även finns i DNA och RNA), sockerarten ribos och tre fosfatgrupper. Den kemiska energin finns i bindningarna mellan fosfatgrupperna.
När cellen behöver energi klyvs en sådan bindning och en fosfatgrupp lossnar. Energi frigörs och ATP omvandlas till ADP (adenosindifosfat) bestående av adenin, ribos och två fosfatgrupper. Fördelen med ATP framför andra energirika molekyler är framför allt att den är enkelt återvinningsbar (ADP laddas med en ny fosfatgrupp tillbaka till ATP) och att energin som frigörs vid varje spjälkning av ATP är lagom liten för att cellulära processer ska kunna drivas utan energislöseri och onödig värmeutveckling.
Kreatin
Kreatin är ett ämne som i muskler omvandlas till fosfokreatin, vilket fungerar som energireserv för att snabbt kunna återbilda ATP under högintensiva ansträngningar:
Fosfokreatin + ADP → Kreatin + ATP
En muskel som har fullt lager av fosfokreatin kan använda detta system i 6–10 sekunder. I idrotter som kräver explosivitet (som tyngdlyftning, korta sprinter och kastgrenar) gör fosfokreatin att idrottaren kan utföra några fler repetitioner eller bibehålla en högre intensitet under några extra sekunder. Många som styrketränar äter därför kreatin som kosttillskott.
Alla organismer använder det kemiska ämnet ATP som energivaluta. Vid cellandningen används den kemiska energin i glukos för att bilda ATP från ADP och fosfat. Den yttersta fosfatgruppen kan senare spjälkas av igen, vilket frigör energi som cellen använder för att driva energikrävande reaktioner.
För att orka att åka Vasaloppet som är 9 mil är det viktigt att utnyttja alla kontroller och fylla på med vätska och energi.
CELLANDNINGEN BESTÅR AV TRE PROCESSER
Utvinningen av energi ur glukos, fettsyror och aminosyror sker via cellandningen, som delas in i tre övergripande processer:
p glykolys
p citronsyracykeln
p elektrontransportkedjan.
I glykolysen bryts glukos ner till pyruvat. Pyruvat transporteras in i mitokondrien och omvandlas till acetyl CoA, som går in i citronsyracykeln. I citronsyracykeln förbränns acetyl CoA, varvid vätejoner och energirika elektroner frigörs. I elektrontransportkedjan utnyttjas energin i elektronerna för att tillverka stora mängder ATP.
Även fettsyror kan brytas ner till acetyl CoA, i en process som kallas
β-oxidation. Vid behov kan vi även utvinna energi ur aminosyror via processer som kallas transaminering och deaminering, där de omvandlas till karboxylsyror som kan gå in i citronsyracykeln.
En del energi frigörs redan under glykolysen (utan syre), men den stora mängden ATP bildas vid nedbrytningen inne i mitokondrierna där syre är elektronacceptorn, vilket är anledningen till att vi behöver andas in syre. Samtidigt bildas koldioxid som restprodukt, vilken vi andas ut.

mag–tarmkanal
cytoplasma
kolhydrater
fetter proteiner
glukos fettsyror aminosyror
glykolys pyruvat
mitokondrie
elektrontransportkedjan
Sammanfattning av de katabola processerna.
betaoxidation
acetyl-CoA
transaminering
deaminering
karboxylsyror
citronsyracykeln
väte + e –
vatten + energi
2
VAR SKER DE KATABOLA PROCESSERNA?
Glykolysen sker i cellens cytoplasma, eller rättare sagt i cytosolen –den del av cytoplasman som innehåller lösta ämnen. Citronsyracykeln och elektrontransportkedjan sker i mitokondrien. Mitokondrien är en organell som finns i så gott som alla eukaryota celler. Den kallas ofta för ”cellens kraftverk” eftersom det är här organismens energi omvandlas, från glukos, fettsyror och aminosyror till energivalutan ATP. Mitokondrien är omsluten av två membran, ett yttre och ett inre. Innanför det inre membranet finns mitokondriens matrix. Det inre membranet är mycket större än det yttre vilket innebär att det blir starkt veckat. Citronsyracykeln och β-oxidationen sker i mitokondriens matrix. Elektrontransportkedjan sker i proteinkomplex som sitter i det inre membranet.

Citronsyracykeln och elektrontransportkedjan sker i mitokondrien. Här avbildad med svepelektronmikroskop och digitalt färglagd.
Glykolys är cellandningens första steg, där glukos klyvs till pyruvat och lite ATP bildas.
Glykolys
Glukos är en molekyl som innehåller sex kolatomer. I glykolysen klyvs glukosmolekylen och bildar två molekyler pyruvat med vardera tre kolatomer. Under reaktionen frigörs lite energi som cellen tar hand om genom att omvandla två molekyler ADP till ATP och två molekyler NAD+ till NADH. NAD är ett så kallat koenzym som transporterar väte och elektroner vid olika ämnesomsättningsprocesser. NAD+ är den oxiderade formen och NADH den reducerade. NADH innehåller betydligt mer kemisk energi än NAD+. I glykolysen kommer både vätet och elektronerna som NAD+ tar upp från glukos.
glukos +2 ADP +2 NAD+ → 2 pyruvat +2 ATP +2 NADH
Samtidigt som en molekyl pyruvat transporteras in i mitokondrien avgår en av kolatomerna i form av koldioxid. Den kvarvarande molekylen innehåller alltså bara två kolatomer, en så kallad acetylgrupp. Acetylgruppen binder till koenzym A (CoA) och bildar molekylen acetyl-CoA . Koenzym A är en bärarmolekyl vars uppgift är att föra in acetylgruppen i mitokondrien och katalysera reaktionen med oxalättiksyra. Därefter återvänder CoA och hämtar nästa acetylgrupp.
Citronsyracykeln
Acetyl-CoA reagerar med en molekyl oxalättiksyra och bildar citronsyra . Oxalättiksyra innehåller fyra kolatomer, vilket medför att den bildade citronsyran får sex kolatomer.
Sedan oxideras citronsyran i ett antal steg. Per varv (det vill säga per acetylgrupp) bildas tre energirika NADHmolekyler, en FADH 2molekyl och en ATPmolekyl (egentligen GTP, som kan omvandlas till ATP). Samtidigt avgår två kolatomer i form av två koldioxidmolekyler, CO2
Till slut finns det kvar en oxalättiksyramolekyl, som innehåller fyra kolatomer och som kan reagera med en ny acetyl CoA. Hela processen upprepas sedan om igen.
Det är värt att notera att hittills har inget av syret vi andas in förbrukats, men koldioxiden vi andas ut har redan bildats.
Citronsyracykeln är cellandningens andra steg, där vätejoner och energirika elektroner frigörs och tas upp av NAD och FAD.
Vad händer vid syrebrist?
Om syre saknas fungerar inte elektrontransportkedjan. Då nybildas inte NAD+ som behövs vid glykolysen och citronsyracykeln. Cellen använder sig då av en nödlösning: pyruvat omvandlas till laktat (mjölksyrans bas) varvid en liten mängd NADH omvandlas till NAD+ , som används för att driva glykolysen (men inte citronsyracykeln) och bilda en liten mängd ATP. Detta sker vid tillfällig syrebrist, som i skelettmuskler vid intensiv träning. Laktatet som bildas transporteras med blodet och tas upp av celler i hjärtat och levern, där det omvandlas tillbaka till pyruvat eller glukos och används som energikälla.
Elektrontransportkedjan
Elektrontransportkedjan är cellandningens sista steg. Det är nu syre förbrukas och den stora mängden ATP bildas.
Elektrontransportkedjan sker i mitokondriens inre membran. På insidan av mitokondriens inre membran plockas vätejoner (H+) och elektroner (e–) av från NADH och FADH2 . Elektronerna tas om hand av proteinkomplex som sitter i mitokondriens inre membran. Från början är elektronerna energirika. Deras energi sjunker gradvis, eftersom den utnyttjas av proteinkomplexen för att pumpa ut vätejonerna till utrymmet mellan mitokondriens inre och yttre membran. Det leder till att en koncentrationsgradient av vätejoner över membranet byggs upp, koncentrationen blir högre i mellanrummet än vad den är innanför mitokondriens inre membran.
Vid det sista proteinkomplexet reagerar elektronerna med vätejoner och syrgas och bildar vatten. Därmed är förbränningen av glukos till koldioxid och vatten fullständig.
Elektrontransportkedjan sker i proteinkomplex som sitter i mitokondriens inre membran.
mitokondriens inre membran mellan yttre och inre membranet innanför inre membranet
ATP-syntas utnyttjar energin i vätejonströmmen in i mitokondriens matrix för att bilda ATP ur ADP och fosfat.
mitokondriens inre membran mellan yttre och inre membranet innanför inre membranet
Den uppbyggda koncentrationsgradienten av vätejoner över mitokondriens inre membran fungerar som ett batteri. För att utjämna koncentrationsskillnaden kommer vätejonerna att vilja färdas tillbaka in till insidan av membranet. Det kan de bara göra genom att passera enzymet ATP-syntas. Enzymet utnyttjar energin i vätejonströmmen för att tillverka ATP ur ADP och Pi (fosfat) enligt reaktionsformeln
ADP + Pi → ATP
För varje glukosmolekyl som förbränns i cellen bildas det 30–32 ATPmolekyler. Anledningen till att det varierar är att processen inte är 100 procent effektiv. Cellmembranen är till exempel inte helt täta, vilket gör att en del vätejoner läcker igenom mellan ATPsyntasmolekylerna.
Gift som blockerar cellandningen
Streptomycin är ett ämne som bildas av Streptomycesbakterier, ursprungligen som försvar mot konkurrerande jordorganismer, men som även använts som antibiotikum. Ämnet binder till bakterieribosomer och hindrar deras proteinsyntes. Eftersom mitokondrien härstammar från en
bakterie har även den ribosomer av bakterietyp. Därför kan streptomycin hindra proteinsyntesen även i våra mitokondrier. Detta är allvarligt eftersom ribosomerna bildar proteiner som är nödvändiga för cellandningen, bland annat membranproteinerna som ingår i elektrontransportkedjan.
SAMMANFATTNING
* Cellandning gör att energin i födan blir tillgänglig så att den kan användas för att tillverka stora molekyler, transportera kemiska ämnen över membran, skicka nervsignaler och dra samman muskelceller.
* Cellandningen består av glykolysen, citronsyracykeln och elektrontransportkedjan.
* Glykolysen sker i cytoplasman, citronsyracykeln och elektrontransportkedjan sker inuti mitokondrien.
* Under glykolysen klyvs en glukosmolekyl samtidigt som det bildas två ATP-molekyler.
* Under citronsyracykeln frigörs
vätejoner och energirika elektroner som tas upp av NAD och FAD.
* Under elektrontransportkedjan bildas den stora mängden ATP samtidigt som syre förbrukas.
INSTUDERINGSFRÅGOR
1. Vad är det huvudsakliga syftet med cellandningen?
2. Vilken molekyl fungerar som cellens ”energivaluta” eller ”bränsle”? Hur frigörs energi från molekylen?
3. Namnge de tre övergripande processer som cellandningen delas in i och ange var i cellen de sker.
4. Vad heter de första stegen i nedbrytningen av kolhydrater, fetter och proteiner, och var i cellen sker de?
5. Varför innehåller NADH mer kemisk energi än NAD+?
6. Vad händer med pyruvatmolekylen innan den går in i citronsyracykeln?
7. Vilka är de viktigaste energirika produkterna som bildas under citronsyracykeln (förutom CO2 och ATP/GTP)?
8. Hur många ATP bildas i var och en av cellandningens tre processer?
9. Beskriv kortfattat hur den stora mängden ATP bildas i elektrontransportkedjan.
10. Vilken restprodukt bildas vid det sista proteinkomplexet i elektrontransportkedjan när syrgas förbrukas?
ÖVNINGAR
Streptomycin
Om en cell utsätts för antibiotikumet streptomycin påverkas mitokondriens proteinproduktion. Ett resultat kan vara att det sista proteinkomplexet i elektrontransportkedjan inte fungerar. Hur kommer detta att påverka cellens totala energiproduktion?
ATP och glukos
Teoretiskt ger en glukosmolekyl 38 ATP-molekyler, men det verkliga utbytet är 30–32. Varför är det verkliga utbytet lägre?
Glukos som energibärare
Glukos är en mycket energirik molekyl och har lägre molmassa än ATP. Varför används inte glukos som energibärare i cellerna i stället för ATP?
Brunt fett
Hos barn och hos människor som vistas i kalla miljöer är förekomsten av brunt fett högre än hos andra personer. Vad är brunt fett och hur fungerar det?
Ämnesomsättning vid energibrist
Hur påverkas ämnesomsättningen om man inte tillför kroppen tillräckligt mycket energi, till exempel vid svält? Varifrån tar vi energin? Hur påverkas cellernas metabolism?
AVSNITT 4: FoTo S y NTES
I
fotosyntesen
tar cyanobakterier,
alger och växter upp ljusenergi
och använder den för att bilda kolhydrater av koldioxid och vatten. I processen bildas även syrgas. Både kolhydraterna och syret är avgörande för livet på jorden.
ORD OCH BEGREPP
Anaerob organism är en organism som kan leva i syrefri miljö.
ATP är en förkortning av adenosintrifosfat, cellens energivaluta.
Calvincykeln är fotosyntesens andra steg där energi används för att omvandla koldioxid till socker.
Fotosyntes är en reaktion där växter använder ljusenergi för att tillverka kolhydrater och syre.
Klorofyll är ett grönt ämne som fångar in solljus.
Kloroplast är den del inuti växtcellen där fotosyntesen sker.
Ljusberoende reaktionen är fotosyntesens första steg där vatten delas upp, syre släpps ut och energi laddas upp.
NADPH är en molekyl som transporterar väte och energi som växter använder för att bygga om koldioxid till socker.
Stroma är en gel som fyller ut kloroplasten och där sockerproduktionen sker.
Tylakoider är sammanhängande membranblåsor inuti kloroplasten där klorofyllet sitter.

Den första fotosyntesen kan ha utvecklats kring heta källor på djuphavets botten.
Fotosyntesens utveckling
Den första fotosyntesen utvecklades redan för omkring 3,5 miljarder år sedan. Bakterier använde solenergi för att bilda kolhydrater av koldioxid, men i stället för vatten använde de vätesulfid och som restprodukt bildades inte syre utan rent svavel (små gula korn). Dessa svavelbakterier har bakterieklorofyll, en molekyl som liknar växternas klorofyll men som fångar upp infraröd strålning i stället för synligt ljus. Infraröd strålning innehåller mindre energi än synligt ljus, men det krävs också mindre energi för att klyva vätesulfid än vatten.
Den syrebildande fotosyntesen utvecklades för omkring 2,7 miljarder år sedan hos cyanobakterier. Cyanobakterier har liksom alger och växter klorofyll och utför fotosyntes där koldioxid och vatten bildar kolhydrater och syre. Utvecklingen av syrebildande fotosyntes påverkade jorden och livet på ett fundamentalt sätt. I början bands syret av järn som oxiderade (rostade) och bildade partiklar som sjönk till havets botten, men efter några hundra miljoner år började atmosfären få en stigande koncentration av syrgas. För cirka 2,4 miljarder år sedan var syrgashalten så hög att många av de anaeroba organismer som levde då dog ut. I stället utvecklades syrgasberoende organismer. Förutom att fotosyntesen bildar kolhydrater och syre, som i dag är livsviktigt, avlägsnar processen växthusgasen koldioxid, vilket sänker temperaturen på jorden, och ur syrgasen bildas ozonskiktet som skyddar oss från solens ultravioletta strålning.
Infraröd strålning i djuphavet
I djuphavsvulkaner finns heta källor som sprutar ut vatten som är extremt hett, upp till 400°C (eftersom trycket i djuphavet är så högt kan vatten nå temperaturer över 100°C). Intill en undervattensvulkan på 2 500 meter djup har forskare hittat gröna svavelbakterier som lever enbart av den
infraröda strålning som vulkanen sänder ut. En del forskare tror att det även var här som den första fotosyntesen utvecklades, bland annat eftersom innan atmosfären syrsattes fanns inget ozonskikt som skyddade från UV-strålning, vilket gjorde miljön närmare vattenytan livsfarlig.
infraröd strålning synligt ljus

Kloroplasten
För cirka 1,5 miljarder år sedan utvecklades kloroplasten. En eukaryot cell slukade en cyanobakterie, men i stället för att bryta ner den som föda uppstod ett symbiotiskt förhållande. Värdcellen fick energirika kolhydrater från cyanobakterien, och bakterien fick skydd av värdcellen. Efter hand blev cyanobakterien mer och mer beroende av värdcellen, bland annat flyttades många av bakteriens gener över till värdcellens DNA. Men än i dag har kloroplasten kvar ett eget litet genom samt egna ribosomer av bakterietyp.
Alla eukaryota organismer som utför fotosyntes (alger, mossor, ormbunkar, barrträd och blomväxter) har kloroplaster där fotosyntesen sker. En kloroplast är omgiven av minst två membran som avgränsar organellen från resten av cellen. Det inre membranet härstammar från cyanobakterien som blev slukad för länge sedan. Det yttre membranet härstammar från den cell som slukade bakterien och blev dess värdcell.
Inuti kloroplasten finns sammanhängande membranblåsor, så kallade tylakoider, där klorofyllet sitter. Gelen mellan tylakoiderna kallas stroma och innehåller ett tiotal enzymer som behövs för att bilda socker, bland annat världens vanligaste protein, rubisco, som binder in koldioxid i fotosyntesen. (Rubisco är ganska långsamt och ineffektivt, därför måste växterna ha stora mängder av det.)
Växtceller med kloroplaster. Varje cell innehåller många kloroplaster.
ljusenergi
Fotosyntesens övergripande reaktion är en förenklad bild.



















Fotosyntesens kemi
Du känner säkert igen fotosyntesens övergripande reaktion sedan tidigare. Men bilden är förenklad. Fotosyntesen delas egentligen in i två steg: ett som kräver ljus och ett som inte gör det.
p Ljusberoende reaktionen utnyttjar ljusenergi för att klyva vatten. Då bildas de energirika molekylerna NADPH och ATP samt biprodukten syrgas.
p Calvincykeln använder energin i NADPH och ATP för att bygga ihop koldioxid till kolhydrater.
LJUSBEROENDE REAKTIONEN
I den första delen av fotosyntesen fångas ljusenergi in av det gröna ämnet klorofyll som sitter i kloroplastens tylakoidmembran. Klorofyllet fungerar som en solfångare eller antenn. Det samlar in ljusenergin och leder den till de två proteinkomplexen fotosystem II och fotosystem I. (Fotosystem I och II är namngivna efter vilken ordning de upptäcktes, men i fotosyntesen används fotosystem II före fotosystem I.)
Fotosyntesen börjar i fotosystem II med att ljus träffar klorofyllmolekyler som sitter fästa i proteinkomplexet. Ljuset ökar energin i klorofyllmolekylerna, vilket gör att elektroner lossnar och slungas iväg. För att ersätta de förlorade elektronerna tar växten upp nya elektroner från vatten. Reaktionen kallas fotolys och innebär att syre bildas:
2H2O + ljusenergi → O2 + 4H+ + 4e–
De energirika lösa elektronerna transporteras via en kedja av proteiner till fotosystem I. Energin i elektronerna används för att pumpa in vätejoner (H+) till tylakoidens insida. Den höga koncentrationen av vätejoner används sedan för att bilda ATP.
Reaktionen fortsätter i fotosystem I . När elektronerna kommer fram hit har de tappat det mesta av sin energi. Ytterligare ljusenergi fångas upp av klorofyllmolekyler för att ladda dem igen. Nu används elektronernas energi för att tillverka det energibärande ämnet NADPH:
NADP+ + H+ + 2e–→ NADPH
NADPH fungerar som ett fulladdat batteri som transporterar väte och energirika elektroner från den ljusberoende reaktionen till Calvincykeln. Där används de för att bygga ihop koldioxid till kolhydrater.
Vid reaktionen i fotosystem II bildas vätejoner (H+). När elektronerna färdas i elektrontransportsystemet pumpas vätejoner från tylakoidmembranets utsida (kloroplastens stroma) till tylakoidernas insida (lumen). Dessutom går det åt vätejoner när NADPH bildas på tylakoidmembranets utsida. Allt detta gör att koncentrationen vätejoner blir lägre på tylakoidmembranets utsida och högre på dess insida.
Det bildas en koncentrationsgradient av vätejoner över tylakoidmembranet. För att utjämna koncentrationsskillnaden kommer vätejonerna att vilja färdas ut ur tylakoiden. Det kan de bara göra genom att passera enzymet ATP-syntas. Enzymet utnyttjar energin i vätejonströmmen för att tillverka ATP ur ADP och Pi (fosfat) enligt följande reaktionsformel:
tylakoidens membran stroma =utanför tylakoiden lumen = tylakoidens insida
ljus
ljus
Bilden visar tre varv av Calvincykeln för att kolatomerna ska räcka till den G3P-molekyl som lämnar cykeln.
CALVINCYKELN
I den andra delen av fotosyntesen (uppkallad efter biokemisten Melvin Calvin som utredde den) utnyttjas de energirika molekylerna ATP och NADPH för att bygga ihop koldioxid till kolhydrater. Reaktionen delas in i tre huvudsteg:
1. I det första steget binds koldioxid (CO2) med hjälp av enzymet rubisco till sockerarten RuBP (ribulos-1,5-bisfosfat) som innehåller fem kolatomer. Molekylen som bildas när koldioxiden binder in får sex kolatomer, men sönderfaller snabbt till två molekyler 3-PGA som vardera innehåller tre kolatomer.
2. I det andra steget används ATP och NADPH för att reducera (tillföra elektroner och energi till) 3-PGA till sockerarten G3P som också innehåller tre kolatomer. En av G3P-molekylerna lämnar cykeln för att bilda större kolhydrater (till exempel glukos) eller andra biomolekyler.
3. I det tredje steget används ATP för att återbilda RuBP från de kvarvarande G3P-molekylerna. När RuBP återbildats kan den användas för att binda mer koldioxid.
För att förstå vad som händer i Calvincykeln måste man hålla räkning på kolatomerna. RuBP innehåller fem kolatomer och G3P innehåller tre kolatomer. För att cellen ska kunna tillverka tre RuBP behövs alltså 15 kolatomer, vilket kan komma från fem molekyler G3P. I varje varv i den icke-ljusberoende reaktionen bildas två molekyler G3P; på tre varv bildas alltså sex molekyler G3P. Fem av dessa behövs för att bilda tre nya molekyler RuBP, den sjätte kan användas till att bilda större kolhydrater.
tylakoider ljus
+ NADP+
kloroplast vatten
syrgas koldioxid socker
Sammanfattande schema över fotosyntesens två reaktioner. De ljusdrivna elektronöverföringarna resulterar i att vatten spjälkas, energirikt ATP och NADPH bildas och syrgas frisätts. ATP och NADPH utnyttjas sedan i Calvincykeln, där koldioxid binds och kolhydrater bildas.
ljusabsorption
klorofyll a klorofyll b karotenoider
fotosyntesens hastighet våglängd (nm)
Klorofyll a, klorofyll b och karotenoider absorberar ljus av olika våglängder. Klorofyll absorberar rött och blått ljus, och reflekterar grönt. Det är därför växter är gröna. Den nedre grafen visar hur snabbt fotosyntesen sker med ljus av olika våglängder.
Vad begränsar fotosyntesen?
Fotosyntesens hastighet beror på flera faktorer: tillgång till vatten, koldioxid och ljus av rätt våglängd för de pigment växten har samt rätt temperatur för att fotosyntesenzymerna ska kunna verka. Den faktor det finns minst av bestämmer takten och kallas den begränsande faktorn.
Hos kaktusar sker fotosyntesen på dagen men koldioxidupptaget på natten. Detta skyddar mot uttorkning eftersom de kan ha sina klyvöppningar stängda på dagen när solen skiner.

Ekologiska anpassningar
Fotosyntesen har anpassats för att passa i olika livsmiljöer där tillgången på ljus och vatten skiljer sig åt.
I tempererade delar av jorden, som i Sverige där det är måttligt ljust, måttligt varmt och relativt god tillgång på vatten, dominerar så kallade C3-växter. De har den typ av fotosyntes som beskrivs ovan, med Calvincykeln där koldioxid binds till två molekyler 3-fosfoglycerat som vardera innehåller tre kolatomer.
På platser med mer ljus, högre temperaturer och mindre vatten dominerar så kallade C4-växter. Hos dem har den först bildade kolföreningen fyra kolatomer. De har ett enzym som binder koldioxid mycket starkt (och som till skillnad från rubisco aldrig binder syre i stället).
Detta gör att de kan utföra fotosyntesens ickeljusberoende reaktion medan klyvöppningarna bara är lite öppna, vilket gör dem bättre skyddade mot uttorkning än C3-växterna. Nackdelen är att denna process kräver mer energi, vilket gör att de utnyttjar ljuset mindre effektivt och är mindre konkurrenskraftiga i miljöer med gott om vatten och svagt ljus.
På mycket ljusa och torra platser, som öknar, finns CAM-växter. De har separerat själva fotosyntesen, som sker på dagen, från upptaget av koldioxid, som sker på natten. På så sätt kan de ha sina klyvöppningar öppna på natten och helt stängda på dagen, vilket skyddar effektivt mot uttorkning. Exempel på CAM-växter är kaktusar och suckulenter.
Vatten absorberar ljus, så i djupt vatten är ljuset begränsat. Dessutom är det andra våglängder som dominerar än på land. Därför har många alger förutom vanligt klorofyll även pigment som absorberar ljus av andra våglängder.
SAMMANFATTNING
* Fotosyntesen är en process där växter bygger energirika kolhydrater av ljusenergi, vatten och koldioxid.
* Fotosyntesen sker i kloroplaster som är gröna organeller i växtcellerna.
* Ljusenergin fångas in av det gröna ämnet klorofyll.
* Den första delen av fotosyntesen kallas ljusberoende reaktionen. Här fångas ljusenergi för att bilda de energirika molekylerna ATP och NADPH samtidigt som syrgas frigörs.
* Den andra delen av fotosyntesen kallas Calvincykeln. Här används energin i ATP och NADPH till att bygga ihop koldioxid till kolhydrater.
* Vissa växter, som kaktusar, har utvecklat specialanpassade varianter av fotosyntes för att klara torka.
INSTUDERINGSFRÅGOR
1. Varför var atmosfären syrefattig i 300 miljoner år trots uppkomsten av syrebildande fotosyntes?
2. Vilka positiva effekter har fotosyntesen för oss människor?
3. Hur uppstod kloroplasten?
4. Hur hänger den ljusberoende reaktionen och Calvincykeln ihop i fotosyntesen?
5. Vad händer med restprodukterna efter fotolys?
6. Hur bildas ATP i fotosyntesen?
7. Vilken uppgift har enzymet rubisco?
8. Vilka faktorer reglerar fotosyntesen?
9. Vad skiljer C3-, C4- och CAM-växters fotosyntes?
ÖVNINGAR
Effektiv fotosyntes
Växter utsätts för väldigt varierande ljusförhållanden.
Ibland är det molnigt och ibland strålar solen. Ibland står solen högt på himlen och ibland lågt. Vilka anpassningar finns för att växter ska kunna fotosyntetisera så effektivt som möjligt?
Ljusexperiment
Planera ett experiment med syfte att undersöka effekten av ljusets våglängd och ljusmängd för en växts tillväxt.
Vad ska du tänka på för att resultatet ska bli så pålitligt som möjligt?
Svarta växter
Om växter hade haft ett svart pigment skulle de absorbera ljus av samtliga våglängder. Varför tror du inte att ett sådant pigment evolverats fram? Hur skulle ett svart pigment påverka växterna?
Calvincykeln
I fotosyntesen kräver Calvincykeln produkterna ATP och NADPH från den ljusberoende reaktionen. Kan man tänka sig att den ljusberoende reaktionen fortsätter att producera ATP och NADPH, även om de inte utnyttjas i Calvincykeln? Förklara.
LA bor ATI o N
Fotosyntes
SYFTE
Att undersöka hur ljus påverkar fotosyntesen och cellandningen genom att mäta förändringar i vattnets pH.
MATERIEL
Tre genomskinliga flaskor (cirka 150 ml) med tättslutande lock.
2–3 lika stora skott av vattenpest (cirka 6 cm).
Kranvatten (rumstempererat).
pH-indikator (BTB och fenolftalein) eller pH-meter. Ljuskälla (lysrör eller glödlampa).
UTFÖRANDE
Dag 1
1. Gör en kontroll av vattnets pH genom att blanda indikatorerna i två små bägare. Använd en droppe fenolftalein i den ena och några droppar BTB i den andra. Notera pH (färg).
2. Placera ett skott av vattenpest i varje flaska med skottets topp riktad mot flaskans botten.
3. Fyll flaskorna helt med vatten och skruva på locket så att inga luftbubblor finns kvar.
4. Ställ flaskorna upp och ner.
5. Placera flaskorna enligt följande: flaska 1: konstant starkt ljus flaska 2: dagsljus (dag/natt) flaska 3: mörker.
6. Låt stå till nästa dag.

Vattenpest kommer från Nordamerika men förekommer förvildad i Sverige. Den bedöms som invasiv.
Dag 2
1. Plocka ur skotten ur var och en av de tre flaskorna.
2. Häll av vattnet från respektive flaska i varsin bägare.
3. Tillsätt indikator och notera färg/pH på samma sätt som i punkt 1, dag 1.
4. Hur har värdena förändrats i förhållande till startvärdena?
REDOVISNING
Beskriv hur pH skiljer sig mellan ljus-, dagsljus- och mörkerbehandling. Förklara resultaten utifrån fotosyntes och cellandning hos växten.
KAPITEL 2:
Bioteknik och genteknik

Vin produceras med hjälp av jästsvampar som bildar alkohol när de utvinner energi ur sockret i druvorna.
AVSNITT 1: Jä SNIN g
Bioteknik är metoder för att producera något med hjälp av levande celler.
Bröd,
öl
och vin tillverkas med hjälp av jästsvampar. Svampcellerna utvinner energi ur kolhydrater utan att använda syre, genom att omvandla kolhydraterna till koldioxid och etanol. Processen kallas jäsning eller alkoholjäsning.
ORD OCH BEGREPP
Anaerob är en process eller miljö som saknar syre.
Bioteknik är när man producerar något med hjälp av celler eller delar av celler.
Cellandning är när celler frigör energi ur energirika molekyler genom att förbränna dem med syre.
Glykolys är cellandningens första steg, där glukos klyvs till pyruvat och lite ATP bildas.
Jäsning är när celler utvinner kemisk energi ur energirika molekyler utan att använda syre.
Jäst är encelliga svampar som förökar sig genom delning eller knoppning.
Kemisk energi är energi som binds eller frigörs när en kemisk reaktion sker.
Koenzym är en molekyl som behövs för att ett enzym ska kunna katalysera en kemisk reaktion.
Pyruvat är en molekyl som bildas i glykolysen.

Historik
Användningen av jäsning för att tillverka alkoholhaltiga drycker eller baka bröd hänger samman med människans övergång från ett liv som jägare och samlare till bofasta jordbrukare. När människor började odla och lagra spannmål lärde de sig också hur dessa råvaror kunde omvandlas till mer hållbara och värdefulla produkter.
De äldsta spåren av jäsning har arkeologer hittat i Turkiet. Det är en ölliknande dryck som är cirka 13 000 år gammal. Även det äldsta jästa brödet har hittats i Turkiet. Det är omkring 8 600 år gammalt. Att vindruvor kunde jäsas till vin upptäcktes troligen något senare. De äldsta arkeologiska fynden av vin är ungefär 8 000 år gamla och hittades i lerkärl i Georgien.
Trots att människan använt jäsning i tusentals år förstod man inte den bakomliggande biologin. Men i mitten av 1800-talet fick den franske kemisten och biologen Louis Pasteur i uppdrag av franska vinproducenter att undersöka varför vin vid tillverkningen ibland blev surt och odrickbart. Pasteur jämförde lyckade viner med misslyckade (sura) i mikroskop. I det lyckade vinet fanns små ovala celler, jästsvampar. I de sura vinerna fanns även mycket mindre organismer, bakterier. Pasteur drog slutsatsen att alkoholjäsning och mjölksyrajäsning (syrning) var två olika biologiska processer. Han utförde experiment och visade att i steriliserad sockerlösning med ren jästkultur bildades alltid alkohol och koldioxid. Om man i stället tillsatte bakterier bildades ättiksyra eller mjölksyra.
Den franske forskaren Louis Pasteur (1822–1895) i sitt laboratorium.
Till en början användes vildjäst som naturligt finns i luften och på råvaror, som på druvor och i säd. Under slutet av 1700-talet började bryggerier och bagerier odla stammar av öljäst och bagerijäst för att få mer förutsägbara resultat. Olika stammar är anpassade för tillverkning av olika typer av vin eller bakning av olika typer av bröd eller bullar. I dag tillverkas kommersiell jäst i stor skala och säljs både färsk och torkad.
Användningsområde
Jäsning används vid tillverkning av de flesta alkoholhaltiga drycker. I cider, öl och vin bildar jästsvamparna den alkohol som finns i den slutgiltiga drycken. För starkare spritsorter som vodka, whisky och rom är jäsning bara det första steget. Sedan koncentreras alkoholen som bildas genom destillering.
Vid brödbak är det koldioxid som är den önskade produkten. Gasen bildar små bubblor som fastnar i degens glutennätverk och får degen att svälla och bli luftig. Den lilla mängd alkohol som bildas avdunstar under gräddningen.
Jäsning används också för att producera bioetanol som används som förnybart bränsle i fordon.

Spritdrycker framställs genom alkoholjäsning som följs av destillering.

Hur gör man?
Principen för jäsning är densamma oavsett om målet är bröd eller alkoholhaltig dryck. Jästsvamparna behöver en syrefattig miljö med tillgång till kolhydrater, till exempel socker eller stärkelse. Kolhydraterna fungerar som jästens mat eller bränsle.
BRYGGA ÖL
Öl görs av malt , som är korn eller annat sädesslag som fått gro och sedan torkats. När kornet gror bildar det amylas för att kunna bryta ner stärkelsen som finns lagrat i fröet. Malten krossas och blandas med varmt vatten. Amylasen i malten aktiveras och bryter ner stärkelsen i säden till sockerarten maltos. Vätskan som bildas kallas vört .
Vörten kokas och kyls sedan till rätt temperatur innan den pumpas in i slutna jästankar. Där tillsätts jäst som jäser maltsockret och bildar etanol och koldioxid. Koldioxiden som bildas i jästankarna ventileras bort. Efter jäsningen filtreras jästen och malten bort. För att kolsyra kommersiell öl tillsätts koldioxid under låg temperatur och högt tryck.
Hantverksöl kolsyras oftast genom att lite socker tillsätts till den färdiga ölen som sedan buteljeras och försluts. Då sker en naturlig kolsyresättning under tryck eftersom sockret omvandlas till etanol och koldioxid. Detta gör även att det kommer att finnas en jästfällning i botten av flaskan.
BRYGGA VIN
Vindruvor krossas för att frigöra saften som är rik på socker. Man tillsätter jäst som jäser sockret och bildar etanol och koldioxid (en del vintillverkare tycker att den vilda jäst som finns på druvorna ger ett bättre vin). Jäsningen sker i en tank med ett jäsrör som tillåter koldioxid att pysa ut men hindrar att syre från luften kommer in. När jästen har omvandlat det mesta av sockret avstannar processen och vinet är färdigt att lagras.
För att göra mousserande vin gör man först ett vanligt vin utan bubblor. Sedan tillsätter man socker och jäst och låter vinet jäsa en andra gång i en sluten behållare. Koldioxiden som bildas blir kvar i vinet i form av kolsyra.
Utrustning för ölbryggning.

BAKNING
En vanlig bröddeg består av mjöl, salt, jäst och vätska i form av vatten eller mjölk. I mjölet finns stärkelse. Enzymet amylas i mjölet bryter ner stärkelse till socker, främst glukos, som jästen använder som bränsle. När en deg jäser sker det i två steg, ett aerobt steg och ett anaerobt steg.
Först sker tillväxt med syre. När degen knådas blandas luft in.
Jästen använder detta syre för att andas och föröka sig. Detta skapar en livskraftig jästkultur.
Inne i den täta degen tar syret snabbt slut. Jästen byter nu strategi till jäsning. Jästen producerar koldioxid som bildar luftbubblor och får degen att resa sig, samt den lilla mängd etanol som bidrar till brödets smak. Det är alltså den syrefattiga miljön inuti degen som är avgörande för att brödet ska bli luftigt, även om skålen med degen står i ett rum fullt av luft.
Jästen i en deg kan även kompletteras med eller ersättas av en surdegskultur med mjölksyrabakterier. Både jäst och surdegskultur förjäser socker under bildning av koldioxid.
Jästsvampar trivs inte i smeten till kakor som innehåller för mycket fett eller socker. I sådana recept används därför bakpulver. Bakpulver innehåller det basiska ämnet natriumvätekarbonat (bikarbonat) och en syra. När dessa löses upp i vätska och hettas upp sker en snabb kemisk reaktion där koldioxid bildas, vilket gör att bakverket reser sig.
Bröddeg jäser när jästsvampar och/eller mjölksyrabakterier bryter ner socker och bildar koldioxid.
Alkoholjäsning. Jästsvampar bildar ATP genom att omvandla glukos till etanol. Samtidigt bildas biprodukten koldioxid.
Hur funkar det?
Jästsvampar är encelliga svampar som är 0,002–0,05 millimeter långa. Det finns omkring 600 olika arter, bland annat öljäst (Saccharomyces carlsbergensis, namngiven efter det danska bryggeriet Carlsberg) som används vid öltillverkning och bagerijäst (Saccharomyces cerevisiae) som används vid både brödbak och vintillverkning. Inom arterna finns flera olika stammar som har lite olika egenskaper.
De flesta arter av jästsvampar har bara vanlig cellandning. De frigör energi (bildar ATP) genom att förbränna socker med syre och bildar koldioxid och vatten. Men öljäst och bagerijäst kan även frigöra energi från socker utan att använda syre och bildar i stället koldioxid och etanol. Det är denna process som kallas jäsning. Medan cellandning med syre ger 30–32 ATP-molekyler per glukosmolekyl ger jäsning endast 2 ATP-molekyler (från glykolysen).
Jäsning börjar på samma sätt som cellandning, med processen glykolys där glukos (druvsocker) omvandlas till ämnet pyruvat. Samtidigt bildas ATP från ADP och ämnet NAD+ omvandlas till NADH.
glukos + 2 ADP + 2 NAD+ → 2 pyruvat + 2 ATP + 2 NADH
NAD är ett koenzym som transporterar väteatomer och elektroner vid olika ämnesomsättningsprocesser. NAD+ är den oxiderade formen och fungerar som elektronacceptor, medan NADH är den reducerade formen och fungerar som elektrondonator. Utan NAD+ stannar glykolysen och därmed ATPproduktionen. Den fortsatta jäsningen återbildar NAD+ från NADH så att glykolysen kan fortsätta och ge energi. Detta sker i två steg. Först omvandlas pyruvat till acetaldehyd och koldioxid (reaktionen katalyseras av enzymet pyruvatdekarboxylas):
pyruvat → acetaldehyd + koldioxid
Sedan omvandlas acetaldehyd till etanol samtidigt som NADH omvandlas till NAD+ (reaktionen katalyseras av alkoholdehydrogenas):
acetaldehyd + NADH + H+ → etanol + NAD+
Den sammanfattade reaktionen från glukos till slutprodukter kan skrivas:
glukos → etanol + koldioxid + energi
C6H12O6 → 2 C2H5OH + 2 CO2 + 2 ATP + värme
SAMMANFATTNING
* Jäsning är en process där jästsvampar omvandlar socker till alkohol och koldioxid utan att använda syre.
* Människan har använt jäsning i tusentals år för att baka bröd och framställa drycker som öl och vin.
* Det var den franske forskaren Louis Pasteur som på 1800-talet upptäckte att det är levande jästsvampar som orsakar jäsningen.
* Vid bakning är det koldioxid som gör degen luftig.
* Vid tillverkning av öl och vin är det alkohol (etanol) som är den önskade produkten.
* Jäsning används för att producera bioetanol, som är ett förnybart bränsle för fordon.
INSTUDERINGSFRÅGOR
1. Vem upptäckte på 1800-talet att levande jästsvampar orsakar jäsning?
2. Vilken är skillnaden mellan alkoholjäsning och mjölksyrajäsning?
3. Hur använder bryggerier vört och malt vid tillverkning av öl?
4. Vilken är den huvudsakliga skillnaden mellan cellandning och jäsning vad gäller syrebehov och energiutvinning?
5. Vilka mikroorganismer kopplade Pasteur till lyckat respektive misslyckat (surt) vin?
6. Vad är definitionen av jäsning i biologiska termer?
7. Hur skiljer sig energimängden ATP som bildas vid jäsning jämfört med vid fullständig cellandning med syre?
8. En deg jäser i ett aerobt och ett anaerobt steg. Vad händer med jästen i det aeroba steget? Varför är det anaeroba steget avgörande för brödets luftighet?
9. Vilket koenzym är nödvändigt för att glykolysen ska kunna fortsätta och producera ATP? Hur återskapas detta koenzym i den fortsatta jäsningen?
10. Skriv den sammanfattande reaktionsformeln för alkoholjäsning, från glukos till slutprodukter (inklusive energi).
ÖVNINGAR
Jästceller
Hur är jästceller byggda och hur förökar de sig?
Glutenfritt bröd
Förklara varför en deg blir större efter jäsning. Ta reda på hur man jäser glutenfria bröd.
Bioetanol
Produktion av bioetanol är en naturlig process som är mer miljövänlig än fossila bränslen, men produktionen är inte utan miljöutmaningar. Vilka är dessa miljöutmaningar? Varför använder vi inte mer bioetanol i Sverige?
Glutenintolerans
Ta reda på hur kroppen påverkas hos en person som är överkänslig för gluten.
LA bor ATI o N
Jäsa deg
INLEDNING
Det finns sedan tusentals år tillbaka en tradition att använda mikroorganismer vid tillverkning av livsmedel. Brödbakning är ett av de äldsta exemplen på bioteknik.
Bröd bakas på mjöl, vatten, salt, lite fett, olika brödkryddor och jäst. Jäst (Saccharomyces cerevisiae) är en liten encellig svamp.
När mjölet fuktats börjar enzymer som finns naturligt i mjölet bryta ner stärkelse till sockerarten maltos, som utgör energi och byggnadsmaterial till jästsvamparna. Jästsvamparna bildar koldioxid som fastnar i nätverket av molekyler i degen – degen jäser. Nätverket i degen består av elastiska trådformade proteiner och kallas med ett gemensamt namn för gluten.
MATERIEL
Torrjäst (1 g).
Olika slags mjöl (75 g).
Vatten (50 ml).
Skål.
Slev eller sked.
Overheadfilm.
Linjal.
Spritpenna (permanent).
Tejp.
Tidtagarur.
UTFÖRANDE
1. Bestäm vilken eller vilka mjölsorter du ska undersöka.
2. Rör ut torrjästen i fingerljummet vatten.
3. Tillsätt mjöl och blanda väl.
4. Rulla ut degen så att den bildar en liten korv och rulla in den i OH-filmen. OH-filmen ska bilda ett rör. Tejpa ihop röret. Markera på filmen degens storlek. OH-rörets diameter kan mätas och plasten graderas så att plastrullens volym kan anges.
5. Notera volymen av degen i plaströret var tionde minut.
REDOVISNING
1. Rita ett diagram som visar hur degen jäste över tiden.
2. Jämför ditt resultat med andra gruppers. För att kunna jämföra resultaten för olika grupper krävs det att alla har samma diameter på röret med OH-film eller att alla räknar ut hur volymen av degen ändras.
3. Skriv en laborationsrapport.
RISKBEDÖMNING
Inga speciella försiktighetsåtgärder behövs. Deg som tillverkas i ett laboratorium ska inte ätas.
FLER PRAKTISKA FÖRSÖK
1. Använd olika jästtyper och jämför resultaten.
2. Jäs degen under olika temperaturer och jämför resultaten.
3. Vilken effekt har askorbinsyra på jäsningsprocessen?
4. Hur påverkar salt jäsningen? Bestäm den optimala saltkoncentrationen.
AVSNITT 2: Syr NIN g
Yoghurt, surkål och kimchi tillverkas med hjälp av mjölksyrabakterier.
Mjölksyrabakterierna utvinner energi ur kolhydrater utan att använda syre genom att omvandla kolhydraterna till mjölksyra. Processen kallas syrning.
Egentligen
är syrning en form av jäsning, mjölksyrajäsning.
ORD OCH BEGREPP
Anaerob är en process eller miljö som saknar syre.
Glykolys är cellandningens första steg, där glukos klyvs till pyruvat och lite ATP bildas.
Konservering är olika metoder för att förlänga ett livsmedels hållbarhet, oftast genom att hindra mikroorganismer från att växa.
Mjölksyra är en syra som bildas vid syrning (mjölksyrajäsning).
Mjölksyrabakterier är en grupp bakterier som genomför syrningsprocessen i livsmedel.
Pyruvat är en molekyl som bildas i glykolysen.
Spontansyrning är syrning som
startar med hjälp av de bakterier som redan finns naturligt på en råvara.
Startkultur är en tillsats av utvalda bakterier som används för att starta och kontrollera en syrning.
Syrning är en syrefri process där bakterier omvandlar socker till mjölksyra för att återbilda NAD+ och få energi.

Historik
Människan har använt syrning för att konservera mat i tusentals år. Det äldsta fyndet är från Sölvesborg i Blekinge där arkeologer har hittat en drygt 9 000 år gammal anläggning där stenåldersjägare syrade stora mängder fisk för att skapa ett hållbart matförråd. I dag syras fisk till surströmming
När människan övergick från att vara jägare och samlare till att bli bofast och hålla boskap upptäckte man att mjölk som fick stå surnade och bildade nya produkter. Denna kunskap ledde till tidiga former av yoghurt och kefir. Mjölken smakade annorlunda men framför allt blev det möjligt att bevara dess näring under lång tid. I Asien utvecklades tekniker för att syra grönsaker, vilket ledde till tidiga former av kimchi. I Europa blev syrad kål, surkål, en livsviktig Cvitaminkälla för den romerska armén och senare för sjöfarare som på så vis kunde undvika sjukdomen skörbjugg, som beror på Cvitaminbrist.
Människan har känt till processen syrning i tusentals år, men inte vetat varför den sker. Man trodde länge att det var en rent kemisk reaktion. Först i mitten av 1800-talet visade den franske kemisten och biologen Louis Pasteur att syrning orsakas av bakterier. Läs mer om Pasteurs upptäckt i avsnittet Jäsning (sidan 49).
Surströmming tillverkas genom syrning.
Yoghurt tillverkas med hjälp av olika arter av mjölksyrabakterier. Mjölksyran gör att mjölkproteinet kasein koagulerar och skapar en krämig konsistens.

Användningsområde
Syrning sänker ett livsmedels pH-värde vilket hämmar tillväxten av oönskade bakterier och därmed förlänger hållbarheten. Processen ger även produkten en karakteristisk syrlig smak och kan förändra dess konsistens. Syrning ökar också näringsvärdet genom att göra näringsämnen lättare för kroppen att ta upp samt genom att bakterierna bildar vissa vitaminer. I de livsmedel där mjölksyrabakterierna fortfarande är levande när man äter dem kan de ha en positiv hälsoeffekt eftersom de kan hjälpa till att upprätthålla en hälsosam tarmflora (levande mikroorganismer som ger hälsofördelar i tarmen kallas probiotika).
Inom mejerinäringen används syrning för att framställa yoghurt, filmjölk, crème fraîche, gräddfil och kefir. Här får mjölksyran mjölkproteinet kasein att koagulera vilket skapar den krämiga texturen. Syrning används också för att förädla grönsaker. Surkål och koreansk kimchi är två exempel, men även gurka, oliver och en mängd andra grönsaker kan syras.
Syrning används även vid tillverkning av charkuterier som salami och isterband. Där bidrar metoden till mognad, smak och livsmedels
säkerhet. Drycken kombucha framställs genom en kombination av jäsning och syrning. Först sker en jäsning där jästsvampar producerar alkohol. Sedan omvandlar syrabildande bakterier alkoholen till olika organiska syror.
Renframställd mjölksyra används dessutom i livsmedelsindustrin som en surhetsreglerande tillsats.
Hur gör man?
Vid traditionell syrning utnyttjas de mjölksyrabakterier som redan finns naturligt i råvaran. Denna process kallas spontansyrning. Spontansyrning kan även användas industriellt, där målet är en säker, standardiserad och förutsägbar slutprodukt. Vid industriell tillverkning av exempelvis surkål kontrolleras den spontana syrningsprocessen genom exakt salthalt, anpassad temperatur och en syrefri miljö. Dessa förhållanden skapar en miljö som gynnar mjölksyrabakterierna och hämmar andra, oönskade mikroorganismer. Detta säkerställer att rätt sorts syrning dominerar och att produkten blir säker och hållbar.

Göra egen surkål
1. Förberedelse: Finstrimla vitkål och lägg den i en stor bunke. Tillsätt salt (cirka 1,5–2 % av kålens vikt).
2. Bearbetning: Massera och krama kålen och saltet med händerna. Saltet drar ut vätska ur kålen och skapar en saltlag som skyddar mot oönskade bakterier.
3. Packning: Pressa ner kålen hårt i en ren glasburk. Vätskan ska stiga och täcka kålen helt. Detta skapar den syrefattiga miljö som mjölksyrabakterierna trivs i.
4. Syrning: Lägg en tyngd på kålen så den hålls under vätskan. Förslut burken löst, eller använd ett jäsrör, och låt den stå i rumstemperatur i 1–3 veckor. Under denna tid kommer bakterierna att omvandla kålens socker till mjölksyra.
Surkål tillverkas av vitkål.

Snabb picklad rödlök med den klassiska 1-2-3-lagen – 1 deciliter ättiksprit, 2 deciliter socker och 3 deciliter vatten – är en kemisk syrning. Detta är inte bioteknik.
Vid industriell syrning är det dock vanligare att man använder specifika startkulturer med önskade mjölksyrabakterier. Processen inleds då med att råvaran, till exempel mjölk, pastöriseras för att avlägsna befintliga mikroorganismer. Därefter tillsätts en renodlad kultur med mjölksyrabakterier. Genom att noga kontrollera temperatur och tid kan man få en jämn kvalitet och en önskad smakprofil. Denna metod är standard vid framställning av de flesta mejeriprodukter som yoghurt, filmjölk och kefir.
KEMISK SYRNING
Vid kemisk syrning eller direkt syrning används inga mikroorganismer utan en färdig syra som ättiksyra, citronsyra eller vinäger tillsätts direkt i livsmedlet. Detta sänker snabbt pHvärdet och ger en syrlig smak. Metoden är vanlig för klassiska ättiksinläggningar som pressgurka, inlagda rödbetor och picklad lök. Även om slutresultatet påminner om traditionell syrning har ingen biologisk process ägt rum.
Hur funkar det?
Mjölksyrabakterier är ett samlingsnamn på bakterier som lever i syrefattiga men näringsrika miljöer och som utvinner energi genom att bryta ner socker till mjölksyra. Det finns mjölksyrabakterier inom flera bakteriesläkten. Inom livsmedelsindustrin används bland annat arter inom släktena Lactobacillus och Bifidobacterium.
Mjölksyrabakterier saknar enzymerna och elektrontransportkedjan som krävs för vanlig cellandning. De kan därför inte bilda ATP genom att förbränna kolhydrater med syre. I stället utvinner de energi genom den process som kallas mjölksyrajäsning, mjölksyrning eller syrning. Syrning börjar, liksom cellandning, med glykolysen som sker i cytoplasman. Under glykolysen bryts en glukosmolekyl ner till två molekyler pyruvat. Samtidigt bildas två ATP-molekyler och två molekyler NAD+ omvandlas till NADH.
NAD är ett koenzym som transporterar väte och elektroner vid olika ämnesomsättningsprocesser. NAD+ är den oxiderade formen och NADH den reducerade. Utan NAD+ stannar glykolysen och därmed ATPproduktionen.
glukos + 2 ADP + 2 Pi + 2 NAD+ → 2 pyruvat + 2 ATP + 2 NADH
Mjölksyrabakterier bildar ATP genom att omvandla glukos till mjölksyra. 2 pyruvat
2 mjölksyra
glukos
Mjölksyra i musklerna?
Vi säger att vi får mjölksyra i musklerna när de arbetar hårt och behöver så mycket ATP att syret som blodet lämnar inte räcker till. Detta sker särskilt under statiskt muskelarbete då den spända muskeln blockerar blodflödet i kärlen. Men egentligen är det mjölksyrans bas laktat som bildas när kroppen bryter ner glukos eller glykogen utan tillgång till syre.
Vid cellandning följs glykolysen av citronsyracykeln och elektrontransportkedjan. Under elektrontransportkedjan återbildas NAD+ från NADH samtidigt som syre konsumeras och stora mängder ATP bildas. Utan syre kan elektrontransportkedjan inte ske, NAD+ tar slut, glykolysen stannar och därmed ATPproduktionen.
Vid syrning följs glykolysen i stället av en reaktion där NAD+ återbildas från NADH samtidigt som pyruvatmolekylen omvandlas till mjölksyra (reaktionen katalyseras av enzymet laktatdehydrogenas):
pyruvat + NADH → mjölksyra + NAD+
I och med att NAD+ återbildas kan glykolysen fortsätta och förse bakteriecellen med en konstant, om än liten, mängd ATP.
Till skillnad från jästsvampar (som bildar etanol och koldioxid) bildar många mjölksyrabakterier ingen gas alls. Det är därför en yoghurt inte bubblar. Men vissa arter mjölksyrabakterier (som ofta är aktiva i början av en surkålsjäsning) bildar lite koldioxid, vilket förklarar varför grönsaksinläggningar kan pysa lite. Den sammanfattande reaktionen kan skrivas:
glukos → mjölksyra + energi
C6H12O6 → 2 CH3CH(OH)COOH + 2 ATP + värme
SAMMANFATTNING
* Syrning är en metod där mjölksyrabakterier omvandlar socker till mjölksyra, en process som sker helt utan syre.
* Syrning används för att konservera mat eftersom mjölksyran skapar en
sur miljö där skadliga bakterier inte trivs.
* Människan har i tusentals år syrat livsmedel som fisk, kål och mjölk för att ge dem längre hållbarhet och en karakteristisk syrlig smak.
* Syrning kan starta naturligt av de bakterier som redan finns på råvaran eller genom att man tillsätter en startkultur.
INSTUDERINGSFRÅGOR
1. Vad är syrning (mjölksyrajäsning)? Vilken slutprodukt bildar bakterierna från kolhydrater?
2. Vilken är den viktigaste funktionen mjölksyran har vid konservering av livsmedel?
3. Nämn en positiv effekt som syrning har förutom konservering och smakförbättring.
4. Varför föredrar livsmedelsindustrin ofta att använda startkultur och pastörisering i stället för spontansyrning?
5. Vad är probiotika?
6. Vad är likheten mellan glykolysen vid cellandning och glykolysen som inleder syrning?
7. Varför är det viktigt att packa kålen hårt och täcka den med vätska vid surkålstillverkning? Koppla svaret till syretillgång och ATP-produktion.
8. Beskriv den kemiska reaktion som sker efter glykolysen vid mjölksyrajäsning. Vad händer med pyruvatet och vad händer med NADH?
9. Vilken viktig egenskap hos syrning förklarar varför yoghurt inte blir bubblig?
10. Vad är skillnaden mellan traditionell biologisk syrning och det som i texten kallas kemisk syrning?
ÖVNINGAR
Mjölksyra på två sätt
Om du tränar hårt kan du få ”mjölksyra” i musklerna.
Mjölksyra bildas även när man gör filmjölk. Vilka likheter och skillnader finns mellan processerna?
Hälsosamma surmjölksprodukter
Den ryske mikrobiologen Ilja Metjnikov, som fick Nobelpriset i början på 1900-talet, hävdade att mjölksyrabakterierna som finns i surmjölksprodukter påverkar hälsan och ger ett längre liv. Ta reda på hur detta stämmer med dagens kunskaper.
Probiotika
Mjölksyrabakterier är vanliga i så kallade probiotika, som sägs vara bra för magen och immunförsvaret. Ge exempel på produkter som innehåller probiotika. Finns det vetenskapligt stöd för att probiotika fungerar – och i så fall i vilka situationer?
Surströmming
Surströmming älskas av vissa och avskys av andra. Hur kan det komma sig att något som luktar så äckligt inte gör den som äter det sjuk?
LA bor ATI o N
Tillverkning av yoghurt och filmjölk
INLEDNING
Yoghurt och filmjölk är typiska surmjölksprodukter. Surmjölk bildas när mjölksyrabakterier omvandlar mjölksockret (laktos) i mjölken till mjölksyra. pH-sänkningen gör att proteinerna i mjölken koagulerar. Bakterierna bildar även smakämnen. Surmjölk bildas naturligt om mjölksyrabakterier från omgivningen hamnar i mjölken och den får stå i någorlunda varm miljö.
Det finns många olika slags mjölksyrabakterier som kan användas för att tillverka specifika surmjölksprodukter som filmjölk, yoghurt, långfil och kefir. Exempelvis innehåller yoghurt en blandning av bakterierna Streptococcus thermophilus och Lactobacillus bulgaricus. Mejerier som tillverkar de olika surmjölksprodukterna utgår från definierade stammar av mikroorganismer för att få fram rätt produkt.
MATERIEL
Yoghurt eller filmjölk med levande bakteriekultur.
Mjölk.
Bägare, skål eller burk.
pH-papper eller pH-meter. Matsked.
Termometer.
Vattenbad eller termos.
UTFÖRANDE
Tillverkning av yoghurt
1. Mät pH i mjölken och yoghurten.
2. Koka upp cirka 100 ml mjölk och låt den svalna till 44 °C.
3. Häll mjölken i en bägare.
4. Tillsätt cirka två matskedar yoghurt och blanda om.
5. Mät pH i blandningen.
6. Häll mjölkblandningen i en termos eller placera den i vattenbad som har temperaturen 41–44 °C. Det är nödvändigt att hela tiden hålla samma temperatur för att rätt bakterier ska tillväxa.
7. Mät pH och följ förändringarna av konsistens i den blivande yoghurten under dagen. Gör en tabell där du antecknar tid, pH och konsistens.
8. Efter cirka 6–8 timmar flyttas mjölkblandningen till kylskåp.
Tillverkning av filmjölk
1. Mät pH på mjölken och filmjölken.
2. Koka upp cirka 100 ml mjölk och låt svalna tills den blir rumstempererad, 20 °C.
3. Tillsätt en matsked filmjölk till mjölken och blanda om.
4. Mät pH på blandningen.
5. Låt mjölkblandningen stå i rumstemperatur, cirka 20 °C, i 18 – 20 timmar.
6. Mät pH och följ förändringarna av konsistens i den blivande filmjölken under dagen. Gör en tabell där du antecknar tid, pH och konsistens.
7. Placera filmjölken i kylskåp.
REDOVISNING
Studera förändringarna av konsistens och pH-värde för mjölkblandningen. Rita ett diagram som visar hur pH förändras över tiden. Markera också i diagrammet om förändringar i konsistens inträffar.

Färsk mjölk har pH 6,5. I stallet finns naturligt flera av de mjölksyrabakterier som används vid tillverkning av syrade mejeriprodukter. Av säkerhetsskäl pastöriseras i dag mjölken innan man tillsätter en känd starterkultur av bakterier.
RISKBEDÖMNING
Om du ska smaka på yoghurt eller fil måste tillverkningen ske i ett kök och med redskap som används för matlagning. Var noga med att tvätta händerna innan du arbetar med matvaror och att hålla arbetsbänken ren och använda rena redskap. Smaka inte på yoghurt eller fil som du använt för att mäta pH och undersöka konsistens.
Risken att odla upp oönskade mikroorganismer i samband med fil- eller yoghurttillverkning är liten.
FLER PRAKTISKA FÖRSÖK
Undersök vad som händer med pH och konsistens under den tid yoghurt eller filmjölk bildas. Mät varje halvtimme. Rita ett diagram där förändringarna i pH-värde avsätts mot tiden. Notera också i diagrammet när förändringar i konsistens inträffar.
AVSNITT 3: I N du ST r IELL TILLVE r KNIN g AV P roTEINE r
Proteiner är stora molekyler med komplexa funktioner. Alla levande celler tillverkar proteiner med DNA som mall genom processerna transkription och translation. Att tillverka proteiner utanför levande celler är extremt komplicerat. Därför låter vi levande mikroorganismer göra det åt oss.
ORD OCH BEGREPP
Enzym är ett protein som fungerar som en katalysator och hjälper till när kemiska reaktioner ska ske i celler.
Fermentor är en stor och sluten tank där man odlar mikroorganismer i en kontrollerad miljö för att producera proteiner.
GMO (genetiskt modifierad organism) är en organism som har en eller flera främmande gener i sin arvsmassa.
Insulin är ett hormon som bildas i bukspottkörteln och som släpper in socker från blodet till cellerna.
Katalysator är ett ämne som snabbar på en kemisk reaktion utan att själv förbrukas.
Plasmid är en extra ringformad DNA-molekyl som används som verktyg för att föra in en ny gen i en mikroorganism.
Substrat är den molekyl som ett enzym binder till och omvandlar till en eller flera produkter.
Transkription är proteintillverkningens första steg då DNA-molekylen läses av och en mRNA-molekyl bildas.
Translation är proteintillverkningens andra steg då mRNA-molekylen översätts till ett protein.

Historik
Under 1800-talet avgränsades proteiner som en grupp kemiska ämnen med det gemensamt att de stelnar när de kokas, precis som äggvita. De kallades därför för äggviteämnen.
På 1800-talet upptäckte man också enzymer. Två franska kemister lyckades 1833 isolera enzymet amylas, som bryter ner stärkelse, från malt (kornfrön som har grott och sedan torkats). I samband med att kornet gror bildar det amylas för det ska att kunna bryta ner stärkelsen som finns lagrat i fröet. Att enzymer är proteiner upptäckte man inte förrän i början av 1900-talet.
Den danska kemisten Christian Hansen utvecklade en metod för att extrahera löpe ur kalvmagar. Löpe är en blandning av flera enzymer som koagulerar och spjälkar proteiner som finns i mjölk, och som kalvar behöver för att kunna utvinna så mycket näring som möjligt ur mjölken de dricker. Löpe från kalvmagar har i tusentals år använts vid osttillverkning för att få proteinerna i mjölken att stelna. Rålöpe (som innehåller enzymet kymosin) blev den första renade enzymprodukten som kunde användas industriellt.
Tillverkning av camembert. Löpe används vid osttillverkning för att proteinerna i mjölken ska koagulera.
Barn med typ 1-diabetes lär sig injicera insulin i låret. Bilden är tagen 1946. På den tiden injicerades insulin bara två gånger dagligen.

På 1800-talet lyckades man även att extrahera enzymet papain från papaya och bromelain från ananas. Papaya och ananas hade sedan länge använts för att möra kött. Kemister var nyfikna på vilka de verksamma ämnena var och såg ett kommersiellt värde i att kunna renframställa enzymer för mörning av kött.
Ungefär samtidigt upptäckte andra forskare att orsaken till typ 1-diabetes är avsaknad av hormonet insulin, ett livsviktigt protein som bildas i bukspottkörteln. Forskare lyckades utvinna insulin ur bukspottkörteln hos hundar, kor och grisar. 1922 gavs insulin för första gången till en patient med diabetes, en 14-årig pojke som var mycket sjuk och inte ansågs ha långt kvar att leva. Bara två timmar efter den första injektionen mådde han betydligt bättre och han levde sedan i många år med regelbundna insulininjektioner (han dog av lunginflammation när han var 26 år). Redan 1923 blev insulin från grisar och kor tillgängligt som läkemedel.
Vid samma tid utvecklades metoder för att odla de bakterier som orsakar difteri respektive stelkramp, utvinna de giftiga proteiner som bakterierna utsöndrar och behandla proteinerna så att de blir ofarliga men behåller sin struktur. Dessa oskadliggjorda gifter används som vaccin mot difteri respektive stelkramp.
Senare utvecklades metoder för att odla fler slags mikroorganismer i industriell skala för att framställa proteiner. Mögelsvampen Aspergillus
oryzae bildar amylas som används inom livsmedelsindustrin för att bryta ner stärkelse till enklare sockerarter. Bakterien Bacillus subtilis bildar flera enzymer som bryter ner proteiner som används i bland annat tvättmedel och inom livsmedelsindustrin.
Med genteknikens framväxt under 1970- och 1980-talen blev det möjligt att flytta specifika gener till mikroorganismer som är bra på att uttrycka proteiner i hög koncentration och som också växer bra i stora tankar. Det första proteinet som utvanns industriellt ur en genmodifierad mikroorganism var insulin. Gener för mänskligt insulin fördes in i E. coli-bakterier och proteinet godkändes som läkemedel 1982. Senare samma årtionde godkändes flera läkemedel med proteiner från genmodifierade mikroorganismer, bland annat humant tillväxthormon och erytropoietin (EPO, ett hormon som stimulerar bildning av röda blodkroppar).
Användningsområde
I dag används enzymer inom många industrier eftersom de är ett effektivt och miljövänligt alternativ till skadliga kemikalier och energikrävande processer. De används främst inom livsmedels och tvättmedelsindustrin, men även vid tillverkning av biobränsle, textil och djurfoder.
TVÄTTMEDEL
Dagens tvättmedel innehåller ofta en blandning av enzymer som är specialiserade på att bryta ner olika typer av fläckar:
p Proteas bryter ner proteinbaserade fläckar som blod, gräs, ägg och svett. Det klipper långa proteinkedjor till mindre, vattenlösliga bitar som kan sköljas bort.
p Lipas attackerar fett- och oljebaserade fläckar från till exempel smör och matolja. Det spjälkar fettmolekyler till mindre delar som sedan kan lösas upp av tvättmedlets övriga ingredienser.
p Amylas är specialiserat på att bryta ner stärkelse. Det är effektivt mot fläckar från potatis, pasta, choklad och såser. Amylas klipper de långa stärkelsekedjorna till mindre sockermolekyler.
p Cellulas är ett enzym som finns hos svampar och bakterier och som bryter ner cellulosa. I tvättmedel hjälper cellulas till att hålla vita textilier vita och minskar mängden noppor på bomullstextilier.

I tvättmedel finns enzymer som bryter ner fläckar.
Laktosfri mjölk är sötare än vanlig mjölk.
SÖTNINGSMEDEL
Proteinet taumatin är 2 000–3 000 gånger sötare än socker och används som bland annat sötningsmedel i glass, drycker och tugggummi. I innehållsförteckningar kallas taumatin för E 957. Taumatin finns naturligt i växten katemfe från Västafrika och utvinns ur den, men det är billigare och effektivare att tillverka proteinet med hjälp av genetiskt modifierade E. colibakterier eller jästsvampar.
LAKTAS OCH LAKTOSFRIA PRODUKTER
Laktosintolerans beror på en brist på enzymet laktas, som behövs för att bryta ner laktos (mjölksocker) till de enklare sockerarterna glukos och galaktos, som kan tas upp av blodet. Utan laktas orsakar laktos magproblem. För att hjälpa personer med laktosintolerans finns olika lösningar som bygger på enzymteknik.
Personer med laktosintolerans kan ta tabletter som innehåller laktas i samband med måltid. Enzymet bryter då ner laktosen direkt i mag–tarmkanalen. Vid tillverkning av laktosfria mejerivaror tillsätts laktas direkt i produkten. Enzymet får verka en tid och bryter ner laktosen till glukos och galaktos. Resultatet är en produkt som smakar sötare men som är fri från laktos.

INSULIN
Diabetes typ 1 beror på brist på hormonet insulin, som är nödvändigt för att kroppens celler ska kunna ta upp glukos ur blodet. Personer med typ 1-diabetes måste ta regelbundna insulininjektioner för att överleva. Tidigare utvanns insulin ur bukspottkörtlar från grisar och kor. Processen var dyr och komplicerad. Slutprodukten kunde också ge allergiska reaktioner. I dag produceras mänskligt insulin med hjälp av genmodifierade bakterier eller jästsvampar.
Hur gör man?
Industriell tillverkning av proteiner är en högteknologisk process som inleds med att man väljer en mikroorganism som är lätt att odla och säker att arbeta med samt effektiv på att producera det önskade enzymet. Mikroorganismerna odlas i sterila och slutna tankar som kallas fermentorer. I fermentorn finns en näringslösning som innehåller allt mikroorganismerna behöver för att växa och föröka sig, till exempel kolhydrater, proteiner och salter. Temperatur, pHvärde och syrehalt kontrolleras noggrant för att skapa optimala förhållanden för mikroorganismen.
Ofta är mikroorganismer som används för industriell tillverkning av proteiner genetiskt modifierade. Man sätter in genen som kodar för proteinet man vill ha med hjälp av hybrid-DNA-teknik (en hybridDNAmolekyl är en molekyl med DNAsegment av olika ursprung som är sammanfogade på konstgjord väg). Genen som kodar för proteinet man vill ha klipps ut med hjälp av restriktionsenzymer och sätts in i en plasmid (en liten ringformad DNAmolekyl) som sedan förs in i mikroorganismen. När mikroorganismen delar sig skapas tusentals identiska kopior av plasmiden och därmed genen. Det är också möjligt att med hjälp av CRISPR-teknik ändra i genen och på så sätt påverka proteinets egenskaper. Exempelvis har många enzymer i tvättmedel blivit modifierade för att göra dem mer stabila och mer effektiva mot fläckar.
När mikroorganismerna har producerat en stor mängd av proteinet måste det separeras från själva mikroorganismerna och resterna av näringslösningen. Mikroorganismerna som används kan antingen utsöndra det bildade proteinet i näringslösningen eller behålla det inne i cellen. Om det behålls inne i cellen måste cellerna sönderdelas. Sedan separeras proteinet från celldelarna och resterna av näringslösningen

En fermentor som används för att odla bakterier för proteintillverkning.
genom centrifugering och filtrering. Det separerade proteinet renas i flera steg för att avlägsna orenheter. Ofta används tekniker som kromatografi. Därefter koncentreras lösningen.
Det rena enzymet blandas med stabiliseringsmedel och andra ämnen för att ge en slutprodukt som är lätt att hantera. Beroende på användningsområde kan produkten vara i flytande form eller i form av ett granulat, vilket är vanligt för till exempel tvättmedel.
Hur funkar det?
Levande celler tillverkar proteiner med gener som bygginstruktioner genom processerna transkription och translation. Det bildade proteinets funktion beror på dess form (struktur). Varje protein har en unik tredimensionell struktur som kan beskrivas i fyra nivåer. Den första nivån är ordningsföljden av aminosyror, aminosyrasekvensen, som kallas primärstruktur. Beroende på aminosyrornas kemiska egenskaper skapas regelbundna tredimensionella sekundärstrukturer som spiraler och veckade plattor. Områdena med sekundärstrukturer binds samman av slingor av peptidkedjan och veckas till en tredimensionell tertiärstruktur som är unik för varje protein. Många proteiner (till exempel hemoglobin) innehåller flera delar. Formen som alla delarna bildar tillsammans kallas för kvartärstruktur.

primärstruktur sekundärstruktur tertiärstruktur kvartärstruktur
Varje protein har en unik tredimensionell struktur som kan beskrivas i fyra nivåer: primärstruktur, sekundärstruktur, tertiärstruktur och kvartärstruktur.
ENZYMER
Enzymer är proteiner som fungerar som katalysatorer och gör att kemiska reaktioner kan ske. Nästan alla kemiska reaktioner som sker i en cell sker med hjälp av enzymer. De deltar i allt från matspjälkning och cellandning till DNAkopiering. Utan enzymer skulle de kemiska reaktionerna i cellerna ske så långsamt att liv inte skulle vara möjligt. Ett enzyms funktion beror på dess form och dess aktiva yta. Varje enzym har en aktiv yta där bara en specifik molekyl, substratet, kan binda. Denna precision kan liknas vid hur en nyckel passar i endast ett visst lås.

När substratmolekylen binder till den aktiva ytan ändrar enzymet form en aning för att omsluta substratet ännu bättre. Denna interaktion gör att de kemiska bindningarna i substratet försvagas, vilket sänker den aktiveringsenergi som krävs för att den kemiska reaktionen som enzymet katalyserar ska starta. Reaktionen sker då mycket snabbare än den skulle ha gjort utan enzymet. Efter att reaktionen är klar har substratet omvandlats till en eller flera produkter. Produkterna har inte längre samma passform till
Enzymet pyruvatkinas katalyserar sista steget i glykolysen när fosfoenolpyruvat omvandlas till pyruvat och energin som frigörs används för att omvandla ADP till ATP.
SAMMANFATTNING
* Proteiner är stora och komplexa molekyler.
* Mikroorganismer, som bakterier och jäst, används för att producera proteiner i industriell skala.
* Vid tillverkning av proteiner är mikroorganismer ofta genetiskt modifierade. En specifik gen för det
den aktiva ytan och släpper därför från enzymet. Det återgår då till sin ursprungliga form, redo att binda in en ny substratmolekyl och katalysera samma reaktion igen. Ett enda enzym kan på detta sätt påskynda den kemiska reaktionen tusentals gånger varje sekund. Det är dessa egenskaper som gör enzymer till så kraftfulla verktyg, både i naturen och i industrin.
önskade proteinet har då förts in i cellens DNA.
* Produktion av proteiner sker i stora tankar som kallas fermentorer där cellerna odlas i en näringslösning under kontrollerade förhållanden.
* Många proteiner som tillverkas är enzymer. De fungerar som katalysa-
torer och används i till exempel tvättmedel för att bryta ner svåra fläckar.
* Tekniken är avgörande inom läkemedelsindustrin. Ett viktigt exempel är produktionen av hormonet insulin för behandling av diabetes.
INSTUDERINGSFRÅGOR
1. Varför är det lättare att producera proteiner med hjälp av mikroorganismer än att tillverka dem i ett laboratorium?
2. Beskriv skillnaden mellan hur insulin framställdes på 1920-talet och hur det framställs i dag. Vilka var nackdelarna med den gamla metoden?
3. Vilka är de fyra huvudtyperna av enzymer som ofta blandas i tvättmedel? På vilka sätt verkar de?
4. Hur tillverkas laktosfria mejerivaror med hjälp av enzymteknik?
5. Beskriv hur hybrid-DNA-teknik fungerar.
6. Vilka roller spelar plasmider och restriktionsenzymer vid genetisk modifiering?
7. Hur påverkar ett enzym aktiveringsenergin för en kemisk reaktion? Vad får detta för konsekvens för reaktionshastigheten?
8. Förklara principen ”lås och nyckel” kring enzymer och substrat.
9. Vilka är de fyra strukturella nivåerna som beskriver ett proteins unika form?
10. Vilka är de två huvudsakliga stegen som sker efter att mikroorganismerna har producerat ett protein? Varför är dessa steg nödvändiga?
ÖVNINGAR
Spjälkning av proteiner Kroppen har flera olika enzymer för spjälkning av proteiner. Exempelvis finns i magen pepsin och i tolvfingertarmen trypsin. Varför räcker det inte med ett proteinspjälkande protein?
Amylas
Amylas används främst för att bryta ner stärkelse. Beskriv i detalj hur amylas spjälkar kolhydrater.
Insulin
I dag utvinns inte insulin från grisar eller kor utan tillverkas på laboratorium. Hur går denna tillverkning till?
Finns det andra proteiner vi människor behöver som tillverkas på liknande sätt?
Specifika enzymer
Många enzymer i kroppen kräver mycket specifika förutsättningar för att vara verksamma. Ge exempel och förklara varför det är viktigt att enzymaktiviteten i kroppen styrs av förutsättningarna.
Enzymer och papper
Ta reda på hur enzymer används inom pappersindustrin för att ta fram produkter med nya egenskaper. Ge exempel på produkter som produceras med enzymer.
Tillverkning av juice
Ta reda på hur enzymet pektinas används vid industriell juicetillverkning.
After Eight
Ta reda på hur chokladbitar (till exempel After Eight), kan ha mjuk mintfyllning inuti en hård yta av choklad.
Möra kött
Kiwi och papaya innehåller enzymer som bryter ner köttproteiner. Ta reda på mer om dessa enzymer och hur de används inom livsmedelsindustrin.
LA bor ATI o N
Reglering av katalas
INLEDNING
Katalas är ett enzym som bryter ner väteperoxid till vatten och syre. Väteperoxid är ett mycket reaktivt ämne som bildas under cellrespirationen. Väteperoxid måste brytas ner omedelbart för att inte orsaka skador på cellerna.
Experimentet undersöker enzymers (katalas) aktivitet.
MATERIEL
Använd lika stora bitar av lever till samtliga test. Lämplig storlek är 0,5 x 0,5 x 0,5 cm. Ett alternativ är att byta ut levern mot den vätska som bildas när man river potatis. Fyll då på vätska till 3 cm höjd i provrören innan start.
Pincett.
Skalpell. Engångspipett.
Provrör och provrörsställ.
Väteperoxid (3–6 %).
CuSO4 (0,05-0,1 M).
UTFÖRANDE
HCl (0,1 M).
NaOH (0,1 M).
Värmeplatta.
Frys.
Linjal.
Kyckling- eller grislever.
Test 1: Utspädning
1. Placera två provrör i en provrörshållare.
2. Tillsätt cirka 1 ml väteperoxid och 1 ml vatten till det ena provröret.
3. Tillsätt cirka 2 ml väteperoxid till det andra provröret.
4. Placera sedan en liten bit lever i de båda provrören.
5. Mät och skriv ner dina observationer.
Test 2: Kopparjoner
1. Placera två provrör i en provrörshållare.
2. Tillsätt cirka 1 ml väteperoxid och 1 ml vatten till det ena provröret.
3. Tillsätt cirka 1 ml väteperoxid och 1 ml kopparjonlösning till det andra provröret.
4. Placera sedan en liten bit lever i de båda provrören.
5. Mät och skriv ner dina observationer.
Test 3: Syra
1. Placera två provrör i en provrörshållare.
2. Tillsätt cirka 1 ml väteperoxid och 1 ml vatten till det ena provröret.
3. Tillsätt cirka 1 ml väteperoxid och 1 ml saltsyra till det andra provröret.
4. Placera sedan en liten bit lever i de båda provrören.
I laborationen beskrivs sex olika deltest. Under utförandet ska du mäta och observera följande:
1. Hur kraftig reaktionen är.
2. Hur högt skummet i provrören stiger (mät med linjal till närmaste millimeter).
3. Vilken eller vilka faktorer som påverkar enzymaktiviteten.
4. Det ena provröret i varje test tjänar som referens.
5. Mät och skriv ner dina observationer.
Test 4: Bas
1. Placera två provrör i en provrörshållare.
2. Tillsätt cirka 1 ml väteperoxid och 1 ml vatten till det ena provröret.
3. Tillsätt cirka 1 ml väteperoxid och 1 ml natriumhydroxid till det andra provröret.
4. Placera sedan en liten bit lever i de båda provrören.
5. Mät och skriv ner dina observationer.
Test 5: Värme
1. Placera en bit lever i en bägare med lite vatten.
2. Placera sedan bägaren i ett kokande vattenbad i cirka 10 minuter.
3. Placera två provrör i en provrörshållare.
4. Tillsätt cirka 2 ml väteperoxid till båda provrören.
5. Tillsätt en bit obehandlad lever till det ena provröret och en bit kokt lever till det andra provröret.
6. Mät och skriv ner dina observationer.
Test 6: Kyla
1. Placera två provrör i en provrörshållare.
2. Tillsätt cirka 2 ml väteperoxid till båda provrören.
3. Tillsätt en bit obehandlad lever till det ena provröret och en bit frusen lever till det andra provröret.
4. Mät och skriv ner dina observationer.
REDOVISNING
Redovisa höjden på skummet som bildas och tidsåtgången till maximal höjd på skummet. Skriv också ner vilka faktorer som påverkar den enzymatiska aktiviteten.
Frågor att besvara:
1. I vilka celler finns katalas? Vilken nytta fyller katalas i cellerna?
2. Vad representerar höjden på skummet? Är höjden ett bra mått på graden av enzymaktivitet?
3. Förklara hur enzymkoncentration respektive substratkoncentration påverkar resultatet.
RISKBEDÖMNING
Använd skyddsglasögon och labbrock. Var försiktig med väteperoxid som är frätande och starkt oxiderande. Låt inte väteperoxiden komma i kontakt med organiska ämnen. Natriumhydroxid och saltsyra är också frätande. Var speciellt observant mot stänk i ögonen. Om du får stänk i ögonen, skölj genast ögonen i rinnande vatten en längre stund och kontakta sedan läkare.
Kopparlösningen hälls i en tungmetallslask. Alla övriga kemikalier kan hällas ut i vasken när experimentet är över. Spola ordentligt. referens
1. Utspädning 1 ml H2O2, 1 ml vatten, lever 2 ml H2O2, lever
2. Kopparjoner 1 ml H2O2, 1 ml vatten, lever 1 ml H2O2, 1 ml Pb2+, lever
3. Syra 1 ml H2O2, 1 ml vatten, lever 1 ml H2O2, 1 ml H+, lever
4. Bas 1 ml H2O2, 1 ml vatten, lever 1 ml H2O2, 1 ml OH–, lever
5. Värme 2 ml H2O2, lever 2 ml H2O2, kokt lever
6. Kyla 2 ml H2O2, lever 2 ml H2O2, frusen lever
referens
AVSNITT 4: P cr
Genteknik är metoder för att analysera eller förändra DNA. De flesta gentekniska metoder kräver relativt stora mängder DNA. Därför måste många metoder kombineras med PCR, ett sätt att kopiera och amplifiera DNA.
ORD OCH BEGREPP
Amplifiera är att öka mängden av något; i PCR-sammanhang betyder det att massproducera kopior av en DNA-sekvens.
Denaturering är det första steget i en PCR-cykel där hög värme används för att separera DNA-dubbelspiralen till två enkelsträngar.
Nukleotider är molekyler som är byggstenar i DNA och RNA.
PCR (Polymerase Chain Reaction) är en metod för att kopiera en del av en DNA-molekyl.
Primer är en DNA-bit som fungerar som startpunkt för DNA-polymeraset och bestämmer vilken del av DNA som ska kopieras.
Replikation den biologiska processen när cellen kopierar hela sin DNA-molekyl så att det bildas en ny likadan.
Taq-polymeras är ett värmetåligt DNA-polymeras-enzym från bakterien Thermus aquaticus
Termocykler är en maskin som utför PCR-reaktioner genom att växla mellan olika förinställda temperaturer.

Historik
På 1970-talet utvecklade biokemisten Frederick Sanger en metod för att analysera nukleotidernas ordningsföljd i en DNAmolekyl (läs mer om DNAsekvensering i avsnittet DNA-sekvensering). Men för att metoden skulle fungera behövdes relativt mycket DNA. För att skapa stora mängder av en viss DNAmolekyl var man tvungen att utföra så kallad genkloning med hjälp av hybridDNAteknik, vilket var mycket tidskrävande (läs om genkloning i avsnittet Kloning).
1983 fick den amerikanske forskaren Kary Mullis en snilleblixt och uppfann PCR (Polymerase Chain Reaction), något han belönades med Nobelpriset för tio år senare. PCR använder upprepade cykler av uppvärmning och nedkylning för att med hjälp av enzymet DNApolymeras exponentiellt kopiera (fördubbla med jämna mellanrum) en avgränsad DNAsekvens.
En utmaning med metoden var att DNApolymeras förstördes vid de höga temperaturer som krävdes. Forskarna var tvungna att tillsätta nytt enzym efter varje uppvärmningscykel, vilket var både omständligt och dyrt. Genombrottet kom 1988 när man började använda det värmetåliga DNApolymeraset Taq-polymeras från bakterien Thermus aquaticus. Denna bakterie lever i heta källor och dess enzym klarar av de höga temperaturerna i PCRprocessen. Nu kunde hela reaktionen automatiseras i en enda maskin.
På bara några timmar kan en bit av en DNAmolekyl kopieras så många gånger att det bildas över en miljard kopior. Denna stora amplifiering (ökning) av DNA är mycket viktig för modern medicin, forskning och kriminalteknik. Utan PCR skulle många av de gentester och genanalyser vi gör i dag inte vara möjliga.
Det värmetåliga enzymet Taq-polymeras hittades hos bakterier som lever i heta källor i nationalparken Yellowstone i USA.

Mullis.
Kary

Vid brottsplatsundersökning används
PCR för att kopiera DNA från spår som saliv, blod eller hårrötter.
Användningsområde
PCRtekniken är ett standardverktyg och används inom många biologiska och medicinska fält. De flesta gentekniska metoder kräver att man även utför PCR för att mängden DNA ska bli tillräckligt stor.
MEDICINSK DIAGNOSTIK
PCR används för att upptäcka förekomsten av virus och bakterier i ett patientprov. Genom att designa reaktionen så att den bara kopierar genetiskt material från ett specifikt smittämne (virus eller bakterie) kan man snabbt ställa diagnoser för sjukdomar som covid-19, influensa, HIV och borrelia, långt innan kroppen hunnit bilda antikroppar.
KRIMINALTEKNIK
PCR används för att masskopiera DNA från minimala biologiska spår från en brottsplats, som saliv, blod eller hårrötter. Den stora mängden kopierat DNA används sedan för att skapa en DNA-profil som kan jämföras med misstänkta personer eller register.
GENTESTNING OCH ÄRFTLIGA SJUKDOMAR
För att diagnostisera genetiska sjukdomar används PCR för att först kopiera upp den specifika genen av intresse. Därefter kan genen analyseras, ofta med DNAsekvensering, för att se om den bär på den sjukdomsorsakande mutationen. Sjukdomar som kan diagnostiseras är till exempel cystisk fibros och bröstcancer.
FORSKNING
Inom biologisk forskning är PCR en vanligt använd metod. Forskare använder den för att studera geners funktion, mäta genaktivitet eller för att jämföra DNA mellan olika arter för att utreda släktskap.
FADERSKAPSANALYS
För att fastställa faderskap används PCR för att kopiera specifika DNAregioner från barnet, mamman och den potentiella pappan. Genom att sedan analysera DNA:t med sekvensering kan det med stor säkerhet bekräftas om en man är pappa till barnet.
Hur gör man?
För att genomföra en PCRreaktion blandar man ett fåtal nyckelingredienser i ett litet plaströr. Följande behövs:
p DNA-prov: Det DNA som innehåller den sekvens man vill kopiera.
p Primrar: Två korta, specialdesignade enkelsträngade DNAbitar som är startpunkter för kopieringen. De är konstruerade för att binda på varsin sida om den DNAsekvens man är intresserad av. Primern utgör startpunkt för DNApolymeraset.
p DNA-polymeras: Enzymet som bygger ihop den nya DNAsträngen. Oftast används det värmetåliga Taq-polymeraset.
p Nukleotider: DNA:s byggstenar som polymeraset använder för att bygga de nya kopiorna.
p Buffert: En lösning som säkerställer att miljön i provröret är optimal för enzymet. Bufferten har bland annat specifik saltkoncentration och pH. När alla ingredienser är blandade placeras röret i en termocykler, en maskin som snabbt kan växla mellan olika temperaturer enligt ett förinställt program.

En PCR-maskin (termocykler) kostar inte mer än att många skolor har råd att köpa in och använda den.
För att kunna massproducera en specifik del av DNA behövs DNA, primrar, nukleotider och Taq-polymeras.
1. Denaturering: 95 °C i 15–30 sekunder. Dubbelspiraler separeras till enkelsträngar.
Hur funkar det?
I levande organismer kopieras DNA varje gång en cell ska dela sig. Kopieringsprocessen kallas replikation och sker genom att enzymet helikas öppnar upp dubbelspiralen på längden och enzymet DNApolymeras sedan bygger på varje enkelsträng med nya nukleotider. Resultatet blir två dubbelspiraler där ena strängen är gammal och den andra är ny.
PCR är en bioteknisk metod för att kopiera DNA. Liksom vid replikation används DNApolymeras för att bygga dubbelsträngat DNA från en enkel sträng. Men till skillnad från vid replikation använder man vid PCR värme för att öppna upp dubbelspiralen på längden.
En PCRreaktion inleds med att man värmer blandningen av DNAprov, primrar, Taq-polymeras och buffert till 95 °C i 2–5 minuter. Då öppnas DNAprovets alla dubbelspiraler upp på längden och bildar enkelsträngar. Samtidigt aktiveras Taq-polymeraset. Efter inledningen sätter en cykel bestående av tre steg igång. Cykeln upprepas cirka 30 gånger och består av följande tre steg:
primer primer
2. Annealing: 50–65 °C i 15–60 sekunder. Primrarna binder till sina specifika startpositioner på enkelsträngarna och är designade för att bara binda på varsin sida om just den DNA-sekvens som ska kopieras. Var och en av de båda primrarna kan nu fungera som en startpunkt för Taq-polymeraset.
3. Elongering: 72 °C i 30–90 sekunder. Med primrarna som startpunkter bygger Taq-polymeras på varje enkelsträng med nya nukleotider, så att det bildas dubbelspiraler där ena strängen är gammal och den andra är ny.
Taq-polymeras primer primer
Taq-polymeras
Taq-polymeras primer primer
Taq-polymeras
Taq-polymeras
Taq-polymeras
primer primer
Taq-polymeras
Taq-polymeras
primer primer
Efter en cykel.
Taq-polymeras
Taq-polymeras primer primer
Taq-polymeras
Taq-polymeras
Efter två cykler.
PCR är en metod som gör det möjligt att kopiera och analysera mycket små mängder DNA. Antalet DNAmolekyler fördubblas alltså i varje cykel. Detta förklarar varför PCR kan skapa en miljard kopior på bara några timmar.
Efter tre cykler.
SAMMANFATTNING
* PCR är en metod som används för att skapa miljontals kopior av en specifik DNA-sekvens.
* Användningsområden för PCR är bland annat att identifiera virus och bakterier och skapa DNA-profiler för brottsutredningar.
* Det värmetåliga enzymet Taq-polymeras möjliggör den automatiserade och cykliska processen i PCR.
* För att kunna kopiera DNA med PCR-metoden måste man blanda ett DNA-prov med primrar, nukleotider och ett polymerasenzym.
* Kopieringen i en PCR-maskin sker genom upprepade cykler av förändringar i temperatur som får DNA att delas och byggas på.
* PCR-metoden ger exponentiell ökning av DNA eftersom mängden kopior fördubblas för varje cykel som körs.
INSTUDERINGSFRÅGOR
1. Vad står förkortningen PCR för? Vilken är metodens huvudsakliga funktion i biotekniska sammanhang?
2. Vad betydde upptäckten av Taq-polymeras för möjligheten att kopiera DNA?
3. Nämn tre viktiga användningsområden för PCR-teknik.
4. Vilka uppgifter har de nyckelingredienser som måste blandas för att en PCR-reaktion ska ske?
5. Vad är en primer i PCR-sammanhang? Vilken funktion har den?
6. Vad heter den maskin som utför PCR-reaktionen? Hur fungerar den?
7. I cellen används enzymet helikas för att öppna DNA-spiralen. Hur sker detta i en PCR-maskin?
8. Beskriv vad som händer i annealingsteget.
9. Varför tar elogeringssteget olika lång tid? Vilket enzym är det som är aktivt under detta steg?
10. På en brottsplats finns ofta väldigt små biologiska spår (till exempel saliv). Varför är PCR en nödvändig förutsättning för att kunna skapa en DNA-profil utifrån spåren?
ÖVNINGAR
Termocykel
Ta reda på varför det krävs värme när man vill kopiera DNA i en termocykler till skillnad från vid replikation.
Bindningsstyrka
Varför är det just bindningarna mellan kvävebaserna som lossnar under denatureringsfasen och inte exempelvis bindningarna mellan deoxiribos och fosfatgrupp?
PCR och eDNA
PCR används för artidentifiering och övervakning av biologisk mångfald från vattenprover. Man undersöker då mycket små mängder eDNA (environmental DNA), genetiskt material som organismer lämnar efter sig i sin omgivning. På så vis kan man hitta sällsynta eller invasiva arter genom att detektera deras unika DNA-spår som man inte annars hade upptäckt.
a) Vilka är fördelarna med PCR-tekniken i detta fall? Vilka är riskerna?
b) Ta reda på hur eDNA används för att lösa brott.
AVSNITT 5: d NA- SEKVENSE r IN g
Vår genetiska information finns i den unika ordningsföljden av kvävebaser (A, T, C och G) i vårt DNA, vår så kallade DNAsekvens. Att läsa av DNAmolekylens sekvens kallas sekvensering.
Metoden har varit helt avgörande för den explosionsartade utvecklingen av biologisk kunskap de senaste 20 åren.
ORD OCH BEGREPP
Bioinformatik är ett vetenskapligt fält som använder datorkraft och programvara för att analysera och tolka stora mängder biologisk data.
DNA-sekvens är ordningsföljden av kvävebaserna (A, T, C, G) i en DNA-molekyl, vilken utgör den genetiska koden.
DNA-sekvensering är en övergripande term för de metoder som används för att läsa av och bestämma den exakta ordningsföljden av kvävebaser i DNA.
Genom är detsamma som arvsmassa, det vill säga all genetisk information som finns hos en individ.
Kvävebaser är organiska föreningar som innehåller en eller flera kväveatomer och som DNA-molekylens stegpinnar består av.
Mutation är en förändring i en DNA-sekvens.
Nanoporsekvensering är en teknik som i realtid läser av en DNA-molekyl när den passerar genom en mikro -
skopisk proteinpor genom att mäta förändringar i en elektrisk ström.
NGS (Next Generation Sequencing) är en sekvenseringsteknik som bygger på massiv parallell sekvensering, där miljontals DNA-fragment analyseras samtidigt.
Sanger-sekvensering är en sekvenseringsmetod som bygger på att DNA-syntes avbryts vid specifika kvävebaser med hjälp av terminatornukleotider.

Frederick Sanger (1918–2013) var en brittisk biokemist som fick två Nobelpris: 1958 för insulinets fullständiga proteinstruktur och 1980 för utvecklingen av DNA-sekvensering.
Den genetiska sekvensen
Det är ordningsföljden av kvävebaser i varje individs arvsmassa som ger individens dess ärftliga egenskaper. Alla levande organismer har små men betydelsefulla skillnader i sitt DNA. Skillnaderna mellan olika arters och individers DNA är anledningen till skillnaderna mellan våra ärftliga egenskaper, att vi ser olika ut och att vissa drabbas av ärftliga sjukdomar. Hur stora skillnader det är mellan två individers eller två arters DNA visar hur nära släkt de är med varandra. DNAsekvensering kan därför användas för att svara på frågor inom allt från sjukdomsdiagnostik och brottsutredningar till evolutionsforskning.
Historik
Vägen till att kunna läsa livets kod inleddes på 1950-talet då forskare som James Watson, Francis Crick och Rosalind Franklin kartlade DNAmolekylens struktur. Att förstå strukturen var en förutsättning för att kunna läsa den.
Under 1970-talet utvecklade den brittiske biokemisten Frederick Sanger en metod (Sangersekvensering) för att bestämma nukleotidernas exakta ordningsföljd, ett arbete som han fick Nobelpriset i kemi för 1980. På 1980-talet uppfanns PCR, vilket förenklade Sangermetoden. Man började också använda instrument som använde laser och fluorescerande markörer som ökade både hastigheten och noggrannheten. Men metoden var fortfarande mycket dyr och långsam. Den första fullständiga sekvenseringen av ett mänskligt genom utfördes i form av ett enormt internationellt samarbete (Human Genome Project), kostade omkring 2,7 miljarder US dollar och tog över tio år att slutföra, från 1990 till 2001. De stora datamängderna som genererades vid sekvensering ledde till ett nytt vetenskapsfält: bioinformatik, som använder datorkraft för att analysera genetisk information. Under 2000-talet utvecklades en ny sekvenseringsmetod, Next Generation Sequencing (NGS). Denna metod har betydligt större kapacitet och kan mycket snabbare kartlägga en individs hela arvsmassa. Att sekvensera ett komplett mänskligt genom tar i dag ett par dagar, inklusive provberedning och dataanalys.
Nanoporsekvensering, som utvecklades 2014, är en sekvenseringsmetod som gör det möjligt att avläsa mycket långa avsnitt av DNAmolekylen åt gången. En del nanopormaskiner är så små att de kan tas med och användas vid fältstudier på platser långt ifrån närmaste laboratorium.
Användningsområden
DNAsekvensering har många tillämpningar inom vetenskap, medicin och samhälle.
GENTEST FÖR ÄRFTLIGA SJUKDOMAR
Genom att sekvensera en persons DNA kan man identifiera specifika mutationer som orsakar ärftliga sjukdomar, till exempel cystisk fibros, Huntingtons sjukdom och vissa cancerformer. Detta möjliggör tidig diagnos, genetisk vägledning och skräddarsydda behandlingar.
FADERSKAPSANALYS
Genom att jämföra DNA från olika personer går det att ta reda på vilka personer som är nära släkt med varandra. Eftersom ett barn ärver hälften av sitt DNA från mamman och hälften från pappan kan faderskap fastställas med hög precision.
SLÄKTFORSKNING
Med kommersiella DNAtest kan privatpersoner utforska sitt ursprung och hitta okända släktingar. Genom att analysera specifika delar av DNA kan man spåra sina förfäders geografiska ursprung.

DNA-sekvensering kan användas vid släktforskning, bland annat för att bekräfta pappersforskning som utförs med hjälp av kyrkböcker. Den kan också användas för att hitta släktingar till personer som är adopterade eller som har en okänd pappa.
När man preparerar DNA-prov från arkeologiskt material eller en brottsplats måste man använda noggrann sterilteknik för att inte råka förorena provet med sitt eget DNA.
BROTTSUTREDNING
DNAbevisning är ett viktigt verktyg inom modern kriminologi. DNA från hårstrå, blod, saliv eller hudceller som hittas på en brottsplats kan jämföras med det hos olika misstänkta personer.
ARKEOLOGI
Forskare kan extrahera och sekvensera DNA från tusentals år gamla ben, tänder och andra arkeologiska fynd. Detta ger en inblick i historiska populationers liv, deras migrationsmönster, släktskap med nutida folkslag och till och med vilka sjukdomar en person bar på. Forskare har till exempel sekvenserat genomet från neandertalare.
EVOLUTIONSFORSKNING
Genom att jämföra DNAsekvenser mellan olika arter kan forskare förstå hur olika arter har utvecklats och är släkt med varandra. Ju mer lika sekvenserna är mellan två arter, desto närmare släkt är de. Forskarna jämför också DNA från många arter för att se när olika arters utvecklingslinjer skildes från varandra. Människans nu närmaste levande släkting är schimpanser (dvärgschimpans och schimpans), vår sista gemensamma föregångare levde för mellan 6 och 7 miljoner år sedan.


Hur gör man?
Processen för att sekvensera DNA med hjälp av Next Generation Sequencing sker i flera steg.
Provinsamling och DNA-extraktion: Först samlas ett biologiskt prov in, till exempel blod, saliv eller en vävnadsbit. Från detta prov renas DNAmolekylerna fram från andra cellkomponenter som proteiner och fetter.
Preparering: DNAprovet klipps (fragmenteras) ner i små bitar. Bitarna förses med speciella adaptersekvenser i ändarna. Adaptersekvenserna gör att DNAbitarna fäster på ytan där sekvenseringen sker samt fungerar som startpunkter för enzymet DNApolymeras.
Sekvensering: Provet placeras på en glasplatta (flow cell ) som sätts in i en sekvenseringsmaskin. Maskinen genomför miljontals kemiska reaktioner parallellt och läser av basordningen för varje DNAfragment. Resultatet är stora mängder data i form av korta DNAsekvenser.
Dataanalys och bioinformatik: De korta, avlästa sekvenserna är som miljontals pusselbitar. Med hjälp av datorer och bioinformatik pusslas dessa bitar ihop till en lång, sammanhängande sekvens. Denna sekvens kan sedan jämföras med en referenssekvens för att hitta skillnader och unika variationer.
Den speciella glasplatta (flow cell ) som används vid Next Generation Sequencing är mindre än ett kreditkort.

Resultatet av en Sangersekvensering visas som ett diagram med toppar i olika färger som representerar olika nukleotider.
Hur funkar det?
DNAmolekylens kvävebassekvens analyseras med hjälp av en kombination av kemiska, enzymatiska och fysikaliska metoder.
SANGERSEKVENSERING
Vid Sangersekvensering, precis som vid PCR, används enzymet polymeras för att syntetisera DNA. Man kan säga att sekvenseringsreaktionen är en modifierad form av PCR. DNAmolekylen värms upp för att separera de två DNAsträngarna, temperaturen sänks så att en primer kan binda till den enkelsträngade DNAmallen och enzymet DNApolymeras börjar bygga en ny, komplementär DNAsträng från primern. Men vid vanlig PCR tillsätter man bara de fyra vanliga nukleotiderna kopplade till A, T, C respektive G. Vid Sangersekvensering tillsätts även en liten mängd teminatornukleotider. Teminatornukleotiderna är modifierade nukleotider som saknar en viktig hydroxylgrupp, vilket gör att när de infogas i den växande DNA-strängen kan inga fler nukleotider läggas till och syntesen avbryts. De fyra olika terminatornukleotiderna kopplade till A, T, C respektive G är märkta med olika färger för att man ska kunna skilja dem åt.
Efter många temperaturcykler har man fått en stor mängd DNAfragment av alla möjliga längder. Varje fragment slutar med en specifik, känd bas. Fragmenten separeras och sorteras efter storlek, varvid man kan läsa av den sista basen på varje fragment i ordning och på så sätt pussla ihop hela DNAsekvensen.
NEXT GENERATION SEQUENCING
Next Generation Sequencing (NGS) bygger på massiv parallell sekvensering, där miljontals DNAfragment läses av samtidigt i en maskin. Det börjar med att de små enkelsträngade DNAbitarna med adaptrar i ändarna placeras på en speciell platta (så kallad flow cell) som sätts in i en sekvenseringsmaskin. Plattan är täckt med miljontals, tätt packade små DNAdelar som är komplementära till adaptrarna och därför binder till DNAbitarna i provet.
DNAbitarna i provet som nu sitter fast på plattan delas upp i enkelsträngar och multipliceras med hjälp av PCR. Plattan är nu täckt med miljontals kluster av DNAbitar. Varje kluster består av hundratals identiska enkelsträngade DNAbitar.
Därefter börjar själva den massiva parallella sekvenseringen. Maskinen sköljer plattan med DNApolymeras plus nukleotider som är kopplade till en fluorescerande molekyl med olika färg beroende på om nukleotiden innehåller kvävebasen A, T, C eller G. När de fluorescerande nukleotiderna binder till sina komplementära kvävebaser på DNA-bitarna avges små ljusblixtar med olika färg beroende på om nukleotiden innehåller A, T, C eller G. En kamera registrerar vilken färg blixten har i varje kluster. När bilden är tagen avlägsnas de fluorescerande molekylerna så att nästa nukleotid kan läggas till. Denna cykel upprepas hundratals gånger.
Genom att kombinera informationen från alla cykler kan en dator återskapa den fullständiga sekvensen för var och en av de miljontals
DNAdelarna och sedan pussla ihop delarna till DNAprovets fullständiga sekvens. Processen är mycket snabb och effektiv.
1. förberedelse
DNA sönderdelas
adaptrar
2. klusterbildning
DNA binder till plattan
PCR-cykler
DNA-kluster
3. sekvensering 4. dataanalys 4
DNA-bitar med adaptrar fluorescerande nukleotider
T C A G
sekvenseringscykler
överlappande regioner
sekvensbit 1 sekvensbit 2
sekvensbit 3
Next Generation Sequencing. 1) DNA-provet fragmenteras och förses med adaptrar. 2) DNA-bitarna med adaptrar fäster på en platta (flow cell ) och kopieras med hjälp av PCR så att miljontals kluster bildas. 3) Maskinen läser av samtliga kluster parallellt genom att registrera färgen på de fluorescerande nukleotiderna som binds in. 4) Datorn tar fram hela DNA-sekvensen genom att pussla ihop de korta sekvensbitarna med hjälp av överlappande regioner.
sammanställd sekvens
Till vänster: DNA-molekylen öppnas och den ena strängen tar sig igenom poren till den positivt laddade sidan av membranet. Till höger: De olika kvävebaserna påverkar jonströmmen genom poren olika mycket, vilket gör att DNA-sekvensen kan läsas av.
NANOPORSEKVENSERING
Vid nanoporsekvensering används ett syntetiskt membran med biologiska proteinporer. Porerna är så små att enkelsträngade DNAmolekyler precis kan ta sig igenom. DNAprovet placeras på ena sidan membranet. En elektrisk spänning appliceras över membranet, vilket gör att det skapas en jonström genom porerna.
På varje nanopor finns ett motorprotein som öppnar upp DNAmolekylernas dubbelspiraler och matar enkelsträngat DNA genom poren i lagom hastighet. När DNAmolekylen passerar poren påverkar de olika kvävebaserna jonströmmen olika mycket. Känsliga sensorer mäter förändringarna i jonströmmen, och en dator analyserar mönstret av elektriska signaler och översätter det till en DNAsekvens. Detta sker i realtid, alltså samtidigt som sekvenseringen pågår.
karakteristiskt
SAMMANFATTNING
* DNA-sekvensering är en samling analysmetoder som används för att bestämma den exakta ordningsföljden av kvävebaser i en DNA-molekyl.
* Genom att kartlägga en DNAsekvens kan forskare identifiera mutationer, utreda släktskap och förstå grunden till ärftliga egenskaper.
* DNA-sekvensering tillämpas inom bland annat sjukdomsdiagnostik, släktforskning, brottsutredningar och evolutionsforskning.
* NGS är en teknik som läser av miljontals DNA-fragment på samma gång i en och samma maskin.
* Nanoporsekvensering är en teknik där en enskild DNA-molekyl träs genom en proteinpor och sekvensen avläses i realtid via elektriska signaler. T C A G
* Bioinformatik är ett vetenskapligt fält som med datorkraft pusslar ihop DNA-sekvenser till en komplett genetisk kod.
INSTUDERINGSFRÅGOR
1. Vilket är syftet med DNA-sekvensering?
2. Hur kan man avgöra graden av släktskap mellan arter med hjälp av DNA-sekvensering?
3. Vad var ”Human Genome Project”? Vilka utmaningar medförde projektet?
4. Nämn tre olika fält där DNA-sekvensering tillämpas.
5. Vilka förbättringar av Sangersekvenseringen ökade avläsningshastigheten?
6. Vilket är huvudskälet till att NGS är en snabbare metod än Sangersekvensering?
7. Vilka likheter och skillnader finns mellan PCR och Sangersekvensering?
8. Hur läser sekvenseringsapparaten av basordningen under den parallella sekvenseringen vid NGS?
9. Vad är bioinformatik?
10. Förklara principen bakom nanoporsekvensering. Varför används tekniken ofta vid fältstudier?
ÖVNINGAR
DNA-analys
Med enkla medel kan man i dag skicka sitt DNA på sekvensering hos kommersiella företag. Vilka är för- och nackdelarna med detta? Diskutera i grupp.
Personliga mediciner
Den moderna gentekniken ger oss möjligheter att skapa personliga mediciner, mediciner som är speciellt anpassade för just dig och dina genetiska förutsättningar. Resonera kring möjligheter och risker med detta. Diskutera i grupp.
Vem äger den genetiska koden?
Bioinformatik är ett viktigt forskningsfält och tillgången till den genetiska koden för olika organismer och individer ökar hela tiden. Men vem äger egentligen den genetiska koden? Individen, företaget som sekvenserade, sjukvården eller … Diskutera i grupp.
Genteknik och människovärde
Många som fötts med ärftliga sjukdomar oroar sig för att deras barn ska drabbas och ber läkare och forskare om metoder att undvika att barnet blir drabbat. Att sitta öga mot öga med sitt barn som fötts med en smärtsam sjukdom och höra barnet fråga: ”Mamma, pappa, varför tog ni inte bort den där genen?” är något alla föräldrar vill förhindra.
Det finns etiska dilemman kring föräldrars rätt att välja bort embryon för att förhindra allvarliga sjukdomar. Ett barn som föds med Krabbes sjukdom dör ofta före tre års ålder och lider av outhärdliga smärtor.
Diskutera först i små grupper och sedan i helklass.
a) Bör föräldrar ha rätt att välja bort embryon som bär på sjukdomsgener?
b) Vem ska bestämma vilka gener som föräldrar har rätt att välja bort?
c) Är livet värt att leva för barn med Krabbes sjukdom? Varför? Varför inte?
d) Hur skulle du svara om ditt barn frågade: ”Varför tog ni inte bort den där genen?”
AVSNITT 6: cr ISP r
CRISPR är en genredigeringsteknik, alltså en teknik för att göra specifika ändringar i levande organismers DNA.
Med hjälp av CRISPR kan forskare ändra i en bestämd DNAsekvens. Om en befintlig gen har ett litet fel så kan detta korrigeras. En befintlig gen kan också stängas av eller så kan en ny hel gen klistras in.
ORD OCH BEGREPP
Cas9 är ett enzym som fungerar som en molekylär sax och kan klippa av båda strängarna i en DNA-molekyl.
CRISPR/Cas9 är en teknik för att göra exakta förändringar av arvsanlagen hos levande organismer.
Genredigering är en process att medvetet göra specifika ändringar i en organisms DNA-sekvens.
Genterapi är en behandling som går ut på att ändra i arvsmassan för att behandla eller förebygga sjukdom.
GMO (genetiskt modifierad organism) är en organism som har en eller flera främmande gener i sin arvsmassa.
Guide-RNA (gRNA) är en specialdesignad RNA-molekyl som matchar en
specifik DNA-sekvens och fungerar som en guide för att leda Cas9enzymet till rätt klippställe.
Off-target-effekt är en oönskad händelse där CRISPR/Cas9 klipper på ett oavsiktligt ställe i genomet.
Historik
Historien om CRISPR började med grundforskning om bakterier. På 1980-talet upptäckte forskare att hos vissa bakteriers arvsmassa fanns det upprepade DNA-sekvenser. Sekvenserna fick namnet Clustered Regularly Interspaced Short Palindromic Repeats (CRISPR). CRISPR:s funktion var länge ett mysterium, men under 2000-talet insåg forskare att sekvenserna är ett slags arkiv, där bakterien sparar DNA från virus som vid något tillfälle infekterat bakterien. Arkivet fungerar som ett immunologiskt minne. De sparade bitarna av virusDNA används för att bakterien ska känna igen virus som försöker infektera igen. Om det händer klipps viruset sönder av enzymet Cas9 Systemet CRISPR/Cas9 finns hos bakterien Streptococcus pyogenes Andra bakterier och arkéer har liknande immunsystem, men med andra Cas-enzymer och olika sätt att arbeta med CRISPR-arkivet. Detaljerna i hur CRISPR-arkivet är uppbyggt skiljer sig också mellan olika bakterier. Nedanstående gäller för de flesta CRISPR-system.
Själva CRISPR-arkivet består av dels korta, identiska DNA-sekvenser (repetitioner) som återkommer om och om igen, dels unika DNAbitar som bakterien har klippt ut från de virus den tidigare har bekämpat (spacers).
När bakterien attackeras av ett virus transkriberas hela CRISPRarkivet och det skapas en lång RNAmolekyl som innehåller alla repetitioner och alla spacers på rad. RNAmolekylen klipps upp till individuella, användbara guideRNAmolekyler ( gRNA) som var och en innehåller en kort del av en repetition samt en spacer. gRNAmolekylen binder till Casenzymet. Om spacern matchar med det inkräktande virusets DNA (mål-DNA) klipper Casenzymet av virusets DNA och förstör på så sätt inkräktaren.
År 2012 upptäckte forskarna Emmanuelle Charpentier och Jennifer Doudna att de kunde programmera om detta bakteriella försvarssystem till ett universellt verktyg för genredigering. Genom att designa en egen guidemolekyl kunde de styra Cas9 till att klippa vid vilken DNAsekvens som helst i vilken organism som helst. För denna upptäckt fick de Nobelpriset i kemi 2020.
CRISPR/Cas9 är i dag den mest använda genredigeringstekniken. Den liknas ofta vid en molekylär gensax. Med hjälp av CRISPR-systemet kan forskare med stor precision hitta en specifik DNAsekvens i en organisms arvsmassa, klippa i den för att sedan antingen ta bort, ändra eller lägga till genetisk information.

Nobelpristagarna Emmanuelle
Charpentier och Jennifer Doudna upptäckte hur de kunde använda
CRSPR/Cas9 för att redigera gener.
En stor andel av bomull som odlas i USA, Indien och Kina är genetiskt modifierad.

Användningsområde
Möjligheten att redigera gener med precision har gett CRISPR/Cas9 ett brett användningsområde. Inom biologisk grundforskning är det ett viktigt verktyg som används bland annat för att stänga av specifika gener för att förstå deras funktion. Inom medicin används CRISPR/ Cas9 bland annat för att skapa snabba och känsliga diagnostiska test för att upptäcka virusinfektioner.
Inom växtförädling och livsmedelsindustrin används CRISPR/ Cas9 för att producera genmodifierade organismer (GMO). Grödor, djur och mikroorganismer modifieras för att ge dem bättre egenskaper, till exempel mer tåliga eller mer näringsrika. I USA är många GMO-växter och en del djur godkända för kommersiell odling och försäljning. I EU får några GMO-växter importeras och användas i livsmedel. I Sverige har olika branschorganisationer bestämt att deras medlemmar inte ska använda GMO.
Det kanske mest omtalade området är genterapi, behandling av genetiska sjukdomar. Inom genterapi arbetar forskare med att utveckla metoder för att korrigera de genmutationer som orsakar tillstånd som sickelcellanemi och cystisk fibros. Inom humanmedicin har genredigering använts bland annat för att avlägsna HIVvirus från infekterade
celler och förbättra aktiviteten av Tceller vid behandling av cancer. Det finns genterapi som använder CRISPR/Cas9 mot sickelcellanemi. Man tar ut patientens blodbildande stamceller, behandlar dem och återför dem sedan till patienten.
Genredigering med CRISPR/Cas9 har skapat etisk debatt, särskilt kring möjligheten att redigera mänskliga embryon på ett sätt som går i arv till kommande generationer. I dag finns det inga länder där det är lagligt att göra redigering av mänskliga embryon som leder till ärftliga förändringar.
Så gör man
Processen börjar med att forskaren identifierar DNAsekvensen som ska redigeras (målDNA:t). Med hjälp av information om målDNA:t designar man sedan en guideRNAmolekyl (gRNA) som är en perfekt matchning till målDNA:t och guidar nukleasenzymet Cas9 till rätt ställe. Om forskaren vill infoga en korrigering eller en helt ny gen designas även en DNAmall som innehåller den sekvens som genomet ska ha efter reparationen.
Guide-RNA:t blandas med Cas9-proteinet så att de bildar ett komplex. Komplexet och eventuell DNA-mall levereras in i de celler som ska redigeras genom att de paketeras i små fettbubblor (lipidnanopartiklar) som binder till och smälter samman med cellmembranen hos målcellerna eller med hjälp av ofarliga viruspartiklar. När allt är inne i cellkärnan börjar sökandet efter rätt plats att klippa i arvsmassan. När gRNA har hittat mål-DNA:t klipper Cas9-enzymet. Cellen reparerar brottet. Om det finns en DNAmall skriver cellens reparationssystem in den nya sekvensen på klippstället. Om det inte finns någon DNAmall repareras klippet slarvigt, vilket stänger av genen.
Forskaren analyserar med hjälp av bland annat PCR och DNAsekvensering om redigeringen lyckades.
Så funkar det
Processen i cellen sker genom att gRNAmolekylen ihop med enzymet Cas9 skannar av cellens DNA. När gRNA hittar den DNA-sekvens som exakt matchar dess egen kod binder den fast där. Denna inbindning aktiverar Cas9-enzymet, som då klipper av båda strängarna i DNA-molekylen.

Cas9 (blått), gRNA (gult) och mål-DNA (lila).
CRISPR/Cas9-systemet klipper ett dubbelsträngsbrott i mål-DNA. Forskare bygger på konstgjord väg ett guide-RNA som matchar det mål-DNA där de vill ha klippet.
När ett brott på DNAsträngen har uppstått vill cellen omedelbart laga skadan med sina egna reparationssystem. Det är här forskarna kan utnyttja processen för att göra en förändring. Genom att styra reparationen kan CRISPR/Cas9-systemet användas för att stänga av, aktivera eller minska aktiviteten hos gener eller byta ut dem.
Om cellen lagar brottet på ett slarvigt sätt uppstår ofta en mutation som stänger av genen. Men om forskaren tillsammans med CRISPR-komplexet skickar med en DNA-mall så kan cellens reparationssystem använda denna för att laga brottet. DNAmallen innehåller då den sekvens som forskaren vill att genomet ska ha efter reparationen. På så sätt kan man infoga en korrigering eller en helt ny gen.
Cas9 klipper i mål-DNA
mål-DNA
dubbelsträngsbrott i mål-DNA
DNA-mall
cellen får själv försöka reparera hålet, vilket oftast ger fel i DNA-koden
Risker
Den största risken med att använda CRISPR/Cas9 för genterapi är att det kan uppstå klipp på fel ställe, så kallade off-target-effekter. Om guide-RNA:t är designat för att hitta en unik sekvens på 20 kvävebaser kan det finnas andra platser i genomet som matchar gRNA:t nästan perfekt (till exempel med 17 eller 18 matchande kvävebaser). Det kan
Cas9
hända att Cas9-enzymet binder till och klipper dessa nästan-matchande sekvenser, trots att de inte är perfekta. Detta kan leda till att det skapas skadliga mutationer, vilket bland annat kan leda till cancer. Det finns flera sätt att minimera risken för off-target-effekter. Bland annat designas guideRNA:t mycket noggrant. Forskare har också modifierat själva Cas9-enzymet för att göra det mer strikt med var det klipper.
SAMMANFATTNING
* CRISPR/Cas9 är en genredigeringsteknik som fungerar som en programmerbar gensax för att med precision klippa och ändra i en specifik DNA-sekvens.
* Ursprungligen är CRISPR/Cas9 ett immunförsvar hos bakterier, som använder systemet för att känna igen och förstöra DNA från invaderande virus.
* Tekniken styrs av en specialdesignad guide-RNA-molekyl (gRNA) som leder enzymet Cas9 till rätt plats i arvsmassan för att göra ett klipp.
* Efter att Cas9-enzymet har klippt DNA-strängen kan cellens eget reparationssystem antingen stänga av en gen eller klistra in en ny DNA-sekvens från en medskickad mall.
* CRISPR/Cas9 används inom många fält, från grundforskning och växtförädling (GMO) till utvecklingen av genterapi för att behandla ärftliga sjukdomar.
* En risk med tekniken är så kallade off-target-effekter där saxen klipper på fel ställe i genomet.
INSTUDERINGSFRÅGOR
1. CRISPR/Cas9 upptäcktes ursprungligen hos bakterier. Vilken funktion fyller systemet naturligt hos dessa bakterier?
2. Vad sparas i bakteriernas CRISPR-arkiv? Hur används informationen om bakterien angrips på nytt?
3. Vilken funktion har enzymet Cas9 i CRISPR/ Cas9-systemet?
4. Vilken upptäckt gjorde Emmanuelle Charpentier och Jennifer Doudna 2012, som ledde till att de tilldelades Nobelpriset i kemi 2020?
5. Hur används CRISPR/Cas9 inom forskning och medicin?
6. Vad avgör var Cas9 ska klippa i den enorma arvsmassan? Beskriv rollen som gRNA spelar i matchningen.
7. Hur används CRISPR/Cas9 i behandling av till exempel sickelcellanemi?
8. För att redigeringen ska kunna ske måste CRISPR-komponenterna ta sig in i cellkärnan. Nämn två metoder som används.
9. Hur kan forskare utnyttja cellens reparationssystem för att med hjälp av CRISPR-systemet infoga en ny gen?
10. Vad menas med en off-target-effekt? Varför utgör den en risk vid genterapi med CRISPR/Cas9?
ÖVNINGAR
Faror med CRISPR-tekniken
Efter upptäckten och all uppmärksamhet som CRISPR/ Cas9 fick i samband med Nobelprisutdelningen valde en av upptäckarna, Jennifer Doudna, att skriva en bok, Sprickan i skapelsen, om riskerna med den nya tekniken. Vilka risker kan du se med CRISPR-tekniken? Diskutera i grupp.
Gen som gen?
Är det någon skillnad mellan att stänga av sjukdomsframkallande gener och klippa in en frisk gen i genomet?
Framtida CRISPR-teknik
Kommer CRISPR-tekniken att ersätta traditionell genmodifiering? Inom vilka fält har CRISPR-tekniken främst använts hittills?
Förändra gentyper
Diskutera om det är etiskt försvarbart (moraliskt rätt) att förändra dessa gentyper:
a) Gener som orsakar obotliga och dödliga ärftliga sjukdomar.
b) Gener som ger ökad risk för sjukdomar som cancer, hjärtinfarkt, Alzheimers sjukdom och reumatism.
c) Genvarianter som ökar risken för depression, alkoholism och drogmissbruk.
d) Gener som påverkar risken för koncentrationsproblem och olika neuropsykiatriska funktionshinder.
e) Genvarianter som påverkar sannolikheten för att bli storväxt, tondöv eller få bra bollsinne.
AVSNITT 7: K Lo NIN g
En klon är en genetisk kopia. Naturlig kloning är exempelvis när en växt förökar sig med sticklingar eller ett befruktat ägg delar sig och bildar enäggstvillingar.
Artificiell kloning är när människan kopierar en enskild gen, skapar celler med samma arvsmassa som en patient eller skapar en helt ny individ som en genetisk kopia av en annan individ.
ORD OCH BEGREPP
Genkloning är att isolera och kopiera en enskild gen.
In vitro betyder ordagrant ’i glas’ och används när biologiska processer sker utanför en levande kropp.
Kloning är att bilda individer som är genetiska kopior av varandra.
Kärnöverföring är en teknik för att klona däggdjur där cellkärnan från en kroppscell flyttas över till en äggcell vars egen cellkärna har tagits bort.
Pluripotent är förmågan hos stamceller att kunna utvecklas till vilken annan celltyp som helst i kroppen.
Reproduktiv kloning är artificiell kloning med målet att skapa en individ som är en genetisk kopia av en annan.
Surrogatmamma är en hona som bär och föder fram en avkomma som hon inte är genetiskt släkt med.
Terapeutisk kloning är artificiell kloning med målet att skapa stamceller
med en patients arvsmassa för att odla celler och vävnader vid medicinsk behandling.
De tre afghanhundarna Bona, Peace och Hope föddes i Sydkorea 2006 och var världens första klonade honhundar.
Två år senare parades Bona och Hope med Snuppy, den första klonade hanhunden. Nio av de tio valparna var friska och utvecklades normalt.

Historik
Artificiell kloning är när människan med hjälp av genteknik skapar genetiska kopior. Artificiell kloning delas in i tre typer:
p Reproduktiv kloning: att skapa en helt ny individ som en genetisk kopia av en annan individ. Om den första individen är vuxen när den klonas så blir klonen en yngre kopia av originalet. Detta har gjorts med däggdjur men inte människor.
p Terapeutisk kloning: att skapa celler eller vävnader med samma arvsmassa som en patient för att kunna transplantera dessa till patienten och på så sätt behandla en sjukdom.
p Genkloning: att isolera och kopiera en enskild gen.
REPRODUKTIV KLONING
Idén att skapa kopior av en organism är inte ny. Redan 1914 använde den tyske embryologen Hans Spemann hårstrån för att dela befruktade ägg av groddjur och skapade på så sätt konstgjorda enäggstvillingar – de första artificiella klonerna. På 1980-talet utvecklades tekniker för att skapa konstgjorda enäggstvillingar av däggdjur genom att försiktigt dela upp cellerna i mycket tidiga embryon som skapats genom in vitro-fertilisering (IVF, provrörsbefruktning). År 2000 lyckades den första embryodelningen av en primat, en rhesusapa.
Den första kloningen av en utvecklad individ med specialiserade celler gjordes 1962. Den brittiska forskaren John Gurdon ersatte cellkärnan i ett obefruktat grodägg med cellkärnan från en specialiserad tarmcell från ett grodyngel. Det modifierade ägget delade sig och utvecklades till ett grodyngel. Den modifierade grodan var en klon av det grodyngel som tarmcellen kom ifrån. Metoden kallas kärnöverföring.
År 1996 föddes fåret Dolly, som var den första klonen av ett vuxet däggdjur. Dolly skapades genom att cellkärnan i en obefruktad äggcell ersattes med cellkärnan från en kroppscell från juvret hos en sexårig tacka av den vita fårrasen dorset. Den modifierade äggcellen sattes in i en surrogatmamma som tillhörde rasen skotsk blackface. Dolly var en genetisk kopia av det vuxna vita får som cellkärnan kom ifrån.
TERAPEUTISK KLONING OCH IPS-CELLER
Efter Dollys födelse 1996 blev idén om terapeutisk kloning mycket populär. Målet var att skapa celler och vävnader för transplantation. Genom att skapa stamceller med patientens egen arvsmassa skulle man undvika problemet med att kroppen stöter bort de transplanterade cellerna.
Vid terapeutisk kloning använder man kärnöverföring för att ersätta cellkärnan i en obefruktad äggcell med cellkärnan från en av patientens egna celler. Den modifierade äggcellen delar sig och bildar ett tidigt embryo. Efter cirka fem dagar är embryot en ihålig cellblåsa som kallas blastocyst . Inne i blåsan finns en grupp celler som kallas den inre cellmassan. När embryot utvecklas vidare kommer blåsan att bilda fosterhinnorna och moderkakan medan den inre cellmassan kommer att bilda själva embryot. Cellerna i den inre cellmassan tas ut och odlas som så kallade embryonala stamceller (ES-celler). Forskare arbetar med att utveckla metoder för att påverka de patientspecifika ES-cellerna till att bilda det slags celler som patienten behöver. Men ES-celler har väckt stora protester eftersom metoden innebär att man använder tidiga mänskliga embryon. Därför har terapeutisk kloning med modifierade ES-celler konkurrerats ut av ett annat slags stamceller med patientens egen arvsmassa, så kallade inducerade pluripotenta stamceller (iPS-celler).
2006 rapporterade den japanske forskaren Shinya Yamanaka att man kan framställa stamceller från fullt differentierade hudceller hos vuxna individer genom att med hjälp av genteknik tvinga dem att uttrycka en kombination av fyra gener. Dessa iPS-celler har samma

Dolly (till vänster) var det första däggdjur som klonades från ett vuxet däggdjur. Fåret med svart ansikte är Dollys surrogatmamma, det vill säga den vars livmoder hon utvecklades i. Fåret som kroppscellen kom från var helt vitt, precis som Dolly.

Beaglevalparna Magic och Stem föddes i Sydkorea 2009 och skapades genom kärnöverföring. Forskare flyttade cellkärnor från fettstamceller från en vuxen hund till obefruktade äggceller. Äggcellerna sattes in i en surrogatmammas livmoder.
arvsmassa som den vuxna individ som hudcellerna kom från. Att framställa iPS-celler är alltså en form av kloning som inte kräver någon äggcell eller embryonal vävnad. iPS-cellerna kan liksom ES-celler påverkas för att bilda olika slags differentierade celler, vävnader och i framtiden förhoppningsvis även organ.
GENKLONING
Kopiering av en enskild gen görs i dag oftast med PCR . Innan PCR var uppfunnet gjorde man det med hjälp av hybrid-DNA-teknik. Genen klipptes ut med hjälp av restriktionsenzymer och sattes in i en plasmid (en liten ringformad DNAmolekyl) som sedan fördes in i en bakterie som delade sig och skapade tusentals identiska kopior av plasmiden och därmed genen. En hybridDNAmolekyl är en molekyl med DNAsegment av olika ursprung som är sammanfogade på konstgjord väg.
HybridDNAteknik används i dag främst för att tillverka proteiner industriellt.
Användningsområde
Reproduktiv kloning används inom främst djuravel för att skapa kopior av djur med särskilt värdefulla ärftliga egenskaper. Syftet är att låta det värdefulla djuret få större påverkan på aveln än det annars hade kunnat ha. Genom att klona till exempel en värdefull tjur kan ännu fler kor insemineras med hans spermier.
Kina (och USA) är världsledande inom storskalig kommersiell kloning av kor och grisar. Målet är att förbättra landets livsmedelssäkerhet genom att producera stora mängder genetiskt överlägsna djur. Detta görs i princip inte i Europa.
Framgångsrika tävlingshästar klonas också, framför allt i USA. Inom hoppning och dressyr är målet oftast att använda klonen inom avel. Inom hästsport är det vanligt att hingstar kastreras tidigt för att bli lättare och säkrare att hantera. Vid kastrering tas testiklarna bort, så en kastrerad häst kan inte användas för avel. Om en kastrerad häst visar sig vara mycket talangfull är kloning ett alternativ eftersom klonen kan behållas som hingst. Många avelsförbund tillåter inte att kloner registreras i stamboken, men klonens avkomma kan registreras.
Inom hästpolo har flera kloner av en och samma häst använts på tävlingar. I hästpolo byter ryttaren häst flera gånger under en match, och att ha en uppsättning identiska hästar ger en stor fördel eftersom
ryttaren då kan rida på samma sätt under hela matchen. Den argentinske poloryttaren Adolfo Cambiaso vann 2017 en viktig turnering där han red sex olika kloner av hästen Cuartetera.
Även sällskapsdjur klonas. I Sydkorea, Kina och USA finns företag som klonar hundar och katter. Att klona en häst kostar runt 100 000 US dollar, en hund eller katt något mindre.
Reproduktiv kloning har också diskuterats som en möjlig sista utväg för att rädda utrotningshotade arter, men att klona vilda djur är extremt svårt. Reproduktiv kloning av människor anses vara oetiskt och är förbjudet i nästan alla länder.
Terapeutisk kloning för transplantation med specialiserade celler skapade från patientspecifika ES-celler eller iPS-celler är ett hett forskningsområde, och många projekt har kommit så långt att man testar metoderna på patienter i kliniska prövningar. Det handlar om behandling mot bland annat skador efter hjärtinfarkt, ögonsjukdomen makuladegeneration (som skadar gula fläcken i näthinnan) och hjärnsjukdomen Parkinsons sjukdom. I Sverige pågår sedan 2023 en klinisk prövning med nervceller för parkinsonpatienter som har skapats från ES-celler, men dessa celler har inte modifierats med kärnöverföring från patienterna.

Adolfo Cambiaso på en av sina kloner av Cuartetera.
Stamceller odlas i sterila plastkärl.
Hur gör man?
Vid reproduktiv kloning av däggdjur ersätter man cellkärnan i en obefruktad äggcell med cellkärnan i en kroppscell, ofta en hudcell, från djuret som ska klonas. Äggcellens kärna sugs ut med hjälp av en mycket tunn glaspipett. Sedan suger man ut hudcellens kärna och sprutar in den i den tomma äggcellen. Äggcellen innehåller nu samma arvsmassa som djuret som ska klonas. Den modifierade äggcellen stimuleras med en elektrisk stöt för att börja dela sig. Det tidiga embryot placeras i livmodern hos en surrogatmamma där det utvecklas till ett foster. När ungen är färdigutvecklad föds den. Men reproduktiv kloning av däggdjur är svårt, och de flesta modifierade äggceller utvecklas inte till ungar som föds. iPS-celler skapas genom att en liten bit hud (2–3 millimeter i diameter) tas från patienten. Hudbiten hackas i ännu mindre bitar och behandlas med enzymer för att de enskilda cellerna ska lossna från varandra. De enskilda cellerna odlas i en steril plastskål. Cellerna tvingas sedan med hjälp av genteknik att uttrycka en kombination av fyra specifika gener. De fyra genernas proteiner gör att cellerna, som var fullvuxna bindvävsceller, glömmer sin identitet och blir iPS-celler som delar sig och har möjlighet att utvecklas till alla celltyper i kroppen. Generna inducerar alltså cellerna till att bli stamceller, därav namnet. När iPS-cellerna är tillräckligt många behandlas de med olika ämnen för att de ska utvecklas till en viss sorts celler (till exempel nervceller, hjärtmuskelceller eller insulinproducerande βceller). När iPS-cellerna har bildat den önskade celltypen transplanteras dessa tillbaka till patienten.

Ett cellprov tas från en framgångsrik tävlingshäst som är valack, alltså inte fertil.
Cellerna från cellprovet odlas i cellodling.
Från de odlade cellerna tas en cellkärna med tävlingshästens arvsmassa (DNA).
En äggcell tas från en äggdonator, ett brunstigt sto.
Äggcellens cellkärna innehåller hälften av stoets arvsmassa.
Fostret som utvecklas i surrogatmammans livmoder är en klon av tävlingshästen.
Fölet som föds är en hingst eftersom han är en genetisk kopia av tävlingshästen. När han blir könsmogen kan han användas i avel.
Cellkärnan tas bort från äggcellen.
Äggcellen som nu innehåller DNA från tävlingshästen får dela sig och utvecklas några dagar i laboratoriet innan embryot överförs till en surrogatmamma.
Cellkärnan med DNA från tävlingshästen förs in i den tomma äggcellen.
Reproduktiv kloning med kärnöverföring. En hingst som har kastrerats kan inte bli pappa, men om han klonas så kan klonen användas för avel.
Hur funkar det?
Kärnöverföring utnyttjar en process som kallas omprogrammering En vuxen kroppscell är specialiserad, till exempel en hudcell, och har de flesta av sina gener avstängda. Äggcellens cytoplasma innehåller dock proteiner och signalmolekyler som kan nollställa denna specialisering. När den vuxna cellkärnan placeras i äggcellen tvingar dessa faktorer DNA:t att glömma sin identitet och återaktivera de gener som styr fosterutvecklingen. Kärnan blir då pluripotent igen och kan styra utvecklingen av ett nytt embryo.
De fyra gener/proteiner som får vuxna specialiserade celler att glömma sin identitet och bli inducerat pluripotenta stamceller kallas tillsammans för Yamanakafaktorerna, efter forskaren som upptäckte dem. Ett av proteinerna (cMyk) gör att cellerna delar sig och luckrar upp DNAmolekylens struktur så att de andra proteinerna kommer åt. Två proteiner (Oct4 och Sox2) aktiverar gener som måste vara aktiva
En forskare använder en tunn glaspipett för att hålla en obefruktad äggcell under mikroskopet. Med hjälp av en annan pipett (från höger) kommer forskaren sedan att injicera en cellkärna. Proceduren är svår och misslyckas ofta.
för att en cell ska vara en stamcell. Det fjärde proteinet (Klf4) ser till att cellen inte specialiserar sig igen förrän processen är klar. För att iPS-cellerna sedan ska utvecklas till exempelvis nervceller, hjärtmuskelceller eller insulinproducerande βceller behandlas de med ämnen som härmar miljön där de önskade cellerna normalt utvecklas under fostertiden, bland annat olika tillväxtfaktorer och signalmolekyler.
Svårigheter och risker
Omkring 90–99 procent av alla försök att klona ett däggdjur misslyckas. Anledningen är oftast att äggcellens cytoplasma inte lyckas nollställa cellkärnan från det vuxna djuret. Själva den tekniska proceduren när äggcellens kärna tas bort och den vuxna cellkärnan sprutas in är svår och ofta skadas äggcellens cytoplasma. Dessutom är den vuxna kroppscellens DNA-molekyler påverkade av epigenetik och åldrande. Metylgrupper hindrar många gener från att vara aktiva och kromosomernas skyddande ändar (telomerer) har blivit förkortade. Äggcellens cytoplasma har bara några timmar på sig att återställa detta, och det misslyckas ofta.
Att nollställa vuxna celler och tillverka iPS-celler är betydligt lättare. När det gäller iPS-celler är den största svårigheten att få dem att mogna fullt ut till rätt sorts specialiserad cell. Även om forskare kan få iPS-cellerna att mogna en bit på vägen lyckas det ofta inte att få dem fullvuxet stabila och effektiva. När celler specialiseras och mognar naturligt i kroppen utsätts de under många år för en exakt reglerad kombination av tusentals tillväxtfaktorer, hormoner och fysiska signaler. Alla dessa signaler går inte att efterlikna i laboratoriet.
Den största risken med transplantation av celler som tillverkats från ES-celler eller iPS-celler är att det ska bildas cancer. Eftersom de specialiserade cellerna kommer från pluripotenta stamceller finns det en viss risk att enstaka pluripotenta celler följer med vid transplantationen. Om det skulle hända så skulle dessa celler kunna börja dela sig okontrollerat i patientens kropp och bilda tumörer. Därför måste alla celler för transplantation kontrolleras extremt noga för att säkerställa att inga pluripotenta celler finns kvar. I dag har flera hundra patienter behandlats med celler som härstammar från pluripotenta stamceller och ingen tumörbildning har uppstått.
SAMMANFATTNING
* Kloning är att skapa en genetisk kopia.
* Vid reproduktiv kloning tar man kärnan från en vanlig kroppscell. Kärnan placeras sedan i en äggcell som får utvecklas i en surrogatmamma.
* Man klonar framför allt djur för att bevara bra egenskaper inom avel.
Kloning av människor är förbjudet av etiska skäl.
* Terapeutisk kloning används för att skapa stamceller som kan behandla sjukdomar. Metoden är etiskt ifrågasatt eftersom den kräver mänskliga embryon.
* Med iPS-teknik kan man ompro -
grammera vanliga kroppsceller till stamceller. På så sätt slipper man använda embryon.
* Det är svårt att klona hela djur och de flesta försök misslyckas.
* Vid behandling med nya celler från stamceller finns det en risk att tumörer bildas.
INSTUDERINGSFRÅGOR
1. Vilken är skillnaden mellan naturlig och artificiell kloning?
2. Vilka tre typer av artificiell kloning beskrivs i avsnittet?
3. Den första artificiella kloningen genomfördes redan 1914 av Hans Spemann. Hur gick kloningen till?
4. Hur skapades fåret Dolly? Vad gjorde Dolly unik?
5. Vad är syftet med terapeutisk kloning? Varför är metoden kontroversiell?
6. Vad upptäckte Shinya Yamanaka 2006? Varför var upptäckten viktig?
7. Varför klonas just kastrerade tävlingshästar (valacker) inom hästsport?
8. Hur går reproduktiv kloning av däggdjur till?
9. Beskriv vad som händer på cellnivå vid kärnöverföring.
10. Varför är det svårt att få iPS-celler att mogna till fullt fungerande specialiserade celler i ett laboratorium?
ÖVNINGAR
Forskning på stamceller
Forskning på stamceller kan utgå från embryonala stamceller, iPS-celler eller kloning med somatisk cellkärnöverföring. Hur skiljer sig dessa metoder åt? Vilka etiska dilemman uppstår kring var och en av metoderna?
Gamla celler
Celler åldras, precis som vi gör. Ta reda på mer om vad som gör att en cell åldras. Hur påverkar åldrande klonade individer eller organ?
Kloning
Om man stoppar i en cellkärna från en givarindivid i en mottagarcell kommer organellerna att härstamma från mottagarcellen, inte individen man vill klona. Kan detta påverka den klonade individens fenotyp?
Kloning och människovärde
Forskningen kring kloning av människoceller utvecklas hela tiden. Syftena är många, till exempel att ta fram stamceller som kan användas för transplantation eller för att odla vävnader och organ.
Sök information på internet för att ta reda på mer om kloning av människor. Diskutera i grupp.
a) Varför är många människor negativa till kloning?
b) Varför vill människor kunna skapa kloner av sig själva eller andra människor?
c) Vilka fördelar och nackdelar kan det finnas med kloning av människor ur ett medicinskt perspektiv? Ur ett etiskt perspektiv? Ur ett religiöst perspektiv?
d) Är det någon skillnad på att klona en enskild cell, ett organ eller en individ?
e) Hur skulle ett framtidssamhälle kunna se ut där det finns kloner av människor?
f) Skulle kloner av människor kunna påverka människovärdet? Hur då?
g) Skulle det vara rimligt att det fanns företag som klonar människor för att bygga upp ”reservdelslager” med organ som kan användas av den ursprungliga individen? Varför? Varför inte?
